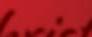

![]()















Today in Mississippi took home two National Rural Electric Cooperative Statewide Editors Association Willie awards and one American Mainstreet Publications award during a September editorial conference in Louisville, Kentucky.
Today in Mississippi’s website won a first place Willie Award in the “Best Digital Communication.”
Steven Ward, editor of Today in Mississippi, won an Award of Excellence/second place Willie Award in the “Best News FeatureLess than 650 words” category for his May 2024 story on the state’s dead tree epidemic.
The Willie Awards, which are held annually, showcase the best writing, photos, and design of statewide electric co-op magazines from all over the country.
Retired Electric Cooperatives of Mississippi (ECM) Senior Vice President of Communications Ron Stewart won the prestigious Lynne Christenson Award of Excellence.
American Mainstreet Publications (AMP) is an advertising cooperative owned by electric co-op statewide publications. The Lynne Christenson Award of Excellence is presented to an AMP member who exemplifies the work ethic, tenacity and professionalism of Lynne Christenson, former advertising manager for Kentucky Living magazine. Christenson was a passionate advocate for electric co-op magazines before losing a battle with cancer in 2015.
Stewart, who retired in February 2022 after 32 years of service to ECM, transformed the flagship monthly publication Today in Mississippi from a tabloid newspaper to a magazine.
The magazine format was launched with the September 2019 issue following two years of prep work.
“For more than 30 years, Ron was deeply involved in cooperative communications e orts in the state of Mississippi. His long tenure at the ECM was highlighted by visionary leadership of their flagship communications tool, Today in Mississippi. But Ron shared his talent and warmth beyond the borders of his adopted home state via his long service to National Country Markets, the cooperative later rebranded to AMP,” according to Stewart’s nomination.
“Ron was a member of NCM/AMP’s board from 1995 to his retirement – an impressive 20-plus-year run. During that time, he and the board helped oversee the steady growth of AMP, the hiring of the cooperative’s current leadership, and the transformation of the cooperative into a modern ad sales agency. He did all this through thoughtful, quiet leadership, a ready smile, and a talent for storytelling.”




While most of the attention in Washington is focused on Presidentelect Donald Trump and the new Congress taking power in January, the current Congress still has time to act on crucial legislation a ecting electric cooperatives in its final “lame duck” session from now until Christmas.
“There’s still a lot on the table before the new administration and new Congress take o ce — including the Farm Bill, disaster relief, and funding the government at the very least,” said Hill Thomas, NRECA’s vice president of legislative a airs.
As dozens of newly elected lawmakers arrived in town in November, NRECA’s team of lobbyists held Co-op 101 sessions to educate them about not-for-profit electric co-ops and the needs of the rural communities they serve.
“In many cases, our statewide managers and grassroots members already have relationships with these new members,” he said.
Among the key co-op issues that the 118th Congress could take up in its final weeks:
The Farm Bill. This five-year bill — set to expire at the end of this year — is full of programs that are essential to co-ops, including funding for broadband, electric infrastructure and rural economic development.
Funding the federal government. With government funding set to expire Dec. 21, lawmakers have several options: pass individual appropriations bills, agree on one big spending bill, or extend current funding levels into next year and let the new Congress deal with the budget. At stake are dozens of important co-op priorities, including funding for the Rural Utilities Service Electric Program to modernize infrastructure and the ReConnect program to bring high-speed internet service to rural communities.
Permitting reform. NRECA and its members have been urging Congress to pass a permitting reform bill that would make it faster and cheaper for co-ops to get federal approval to modernize their systems or simply manage vegetation around power lines. – NRECA



“Improving the quality of life for all those we touch.”
Christmas! I love everything about this time of year. Just the thought of this season brings a smile to my face and evokes a sense of hope, peace, comfort and nostalgia. Recalling family gatherings and traditions warms my heart and fills my senses.
It’s a time of reflection. I’m grateful for my own family as well as my co-op family. At 4-County, we’re driven by a sense of mission and purpose. Our team feels a strong connection to our community and our members, because we live here too.
While many of our community-focused programs and activities such as our annual Toy Drive and Warm Neighbors ramp up this time of year, we have several programs and services in place to help our members year-round. I’d like to remind you about some of these o erings in hopes you’ll find them beneficial.
We hope you’ll take advantage of our online billing services. You can get a look at your daily electric use, billing history and set up alerts and reminders about your 4-County account.
Another service we o er is PrePay, a program intended to help budget your monthly energy costs. 4-County members can pay for electricity before it’s used, then use the electricity until the credit expires. During the time period paid for, you’ll receive regular feedback on your balance.
We also o er energy e ciency programs to save you money and energy. From energy audits to energy use calculators to programs designed to save you energy, to low cost no hassle tips, we’ve got something for everyone.










The 4-County Foundation helps our communities be the best they can be. Since February 2015, participating 4-County members’ utility bills have been rounded up to the nearest dollar. Over $2.2 million dollars in grants have been awarded to non-profit organizations in our service area.
Another of our important investments we make is in our local youth. 4-County has logged hundreds of volunteer hours supporting schools, youth clubs, and programs. Each year, through our Cooperative Youth Leaders program (which we now call Cooperative University), we send a group of high school juniors to Washington, D.C. for a week-long immersion to experience democracy in action.
At the heart of all of these programs is you — the members we proudly serve. Looking back, I’m grateful for so many wonderful community partners and for the positive impact we can continue to make.
This Christmas season, I wish you and your loved ones joy and prosperity. Speaking on behalf of our team at 4-County, I know the future will be be bright, because of you.
Merry Christmas from your 4-County/FASTnet team!

by Brian Clark
CEO/General Manager

This Christmas season, 4-County urges you to consider giving yourselves the gift of energy e ciency.
Early predictions indicate that this winter could be a harsh one. That, combined with a significant base rate increase in October from the Tennessee Valley Authority and a slight increase to 4-County rates, makes for a perfect recipe of energy e ciency. So, let’s get the energy-e ciency e orts kicked o before the extreme cold weather gets here.
Here are some stocking stu ers that can save you money:
• LED light bulbs are an easy way to increase e ciency in your home. From indoor bulbs for your lamps, recessed lighting and hanging fixtures to outdoor lighting, such as flood lamps and even decorative lighting strands, there’s an LED bulb for everyone.
• Water-saving showerheads are also a great gift option. Switching to a water-saving showerhead could provide significant savings.
• Caulking supplies and weather strips are perfect energy-saving gifts.
From all of us here at 4-County, have a happy, safe, energy-e cient holiday season.
Warm Neighbors is a special project that gives 4-County members an avenue to help their neighbors. The Warm Neighbors fund was created to assist 4-County members who find themselves in a one-time emergency, such as an unexpected hospitalization, a job layo , or the loss of the family breadwinner. By paying $1 extra on your 4-County electric bill, you will buy a dollar’s worth of electricity for the home of a neighbor who needs it in the nine-county area served by 4-County. Administered by the Salvation Army, in cooperation with 4-County and area United Way agencies, Warm Neighbors funding comes solely from the voluntary contributions of 4-County members. To participate in Warm Neighbors, contact 4-County at 1-800-431-1544.
























Aby Miranda Boutelle
Let’s start with cooking your meal. Your electric oven is typically the highest-wattage appliance in the kitchen. Yet, people usually don’t turn their ovens on for long periods of time. Assuming an average oven wattage of 3,000 and an average cost of $0.16 per kilowatt-hour, according to the United States Energy Information Administration, it costs $0.48 an hour. Let’s say you use your oven for four hours to make a special meal. That’s less than $2 of electricity. While that may not seem like a big deal now, operating your oven for four hours every day is $700 a year.
Using smaller appliances instead of your oven can help you save. A slow cooker uses between 100 and 450 watts, which is significantly less than an electric oven at 2,000 to 5,000 watts. That means you can use a slow cooker for a longer period and still use less energy.
Opt for your microwave or toaster oven to reheat or cook smaller items. The microwave uses significantly less energy than the oven. A toaster oven uses about half the energy of a conventional oven, according to Energy Star®.
You also want to avoid turning on your oven and leaving the door open to heat your home. This can break your oven and be a safety hazard, especially with gas ovens that can cause carbon monoxide buildup.
When cooking on the stovetop, match the pot or pan size to the burner. Lids help your pots retain heat, which cooks food faster and wastes less heat. Keep your stovetop clean to ensure the appliance heats evenly.
If you’re looking to upgrade your stovetop, consider switching to an induction cooktop. It uses an electromagnetic field below the surface to heat pots and pans directly. This provides more precise heat, faster cook times and higher e ciency. It can also improve the air quality in your home when compared to a gas cooktop.
In my experience, people like to gather in the kitchen during parties. To avoid overheating your guests in a room that has a hot oven, turn your thermostat down a few degrees before guests arrive.
Next, let’s look for refrigerator savings. The gaskets on your refrigerator doors should make a tight seal to keep in cold air. Make sure you clean and maintain them or replace them if necessary. Don’t let frost
The holiday season brings opportunities to enjoy meals with friends and family, leading to spending more time in the kitchen. Whether hosting a few or a crowd, consider making new energy e ciency traditions this year with these tips to manage your energy use.
build up in the freezer, which can decrease e ciency and make your freezer work harder to maintain a balanced temperature.
Wait until food cools before putting leftovers in the fridge. Putting hot food in the refrigerator results in more energy used to cool it down. Aim for about 30 minutes of cool time. Perishable food should be refrigerated within two hours after it is cooked, according to the United States Department of Agriculture.

When shopping for new kitchen appliances, look for the Energy Star® logo. Energy Star® certification indicates the appliance is optimized for e ciency and energy savings, while also providing improved performance, quality, and durability.
Setting your refrigerator colder than needed wastes energy. The U.S. Department of Energy recommends 37 degrees for the refrigerator and 0 degrees for the freezer. Use an appliance thermometer to monitor the temperature.
When it comes to cleanup, run full loads of dishes in the dishwasher — being careful not to block any moving parts. Use eco mode if your dishwasher has that setting. If you are in the market for new appliances, select Energy Star® models.
Whatever you choose to cook or how you cook it, keep in mind these simple tips to make your kitchen more e cient and save energy this holiday season.
Miranda Boutelle is the chief operating o cer at E ciency Services Group in Oregon, a cooperatively owned energy e ciency company.































4-County Electric Power Association and FASTnet are encouraging members and customers to help make Christmas better and brighter for area children by taking part in their annual Toy Drive.





Drop-o boxes will be in 4-County o ces this month through Dec. 13. The co-op is asking its members, employees and the public to drop o a new, unwrapped toy in one of the boxes located in the 4-County o ce nearest you.



Collected toys will be delivered to the Salvation Army who will distribute toys throughout the 4-County service area. Last year, employees and members dug deep and collected nearly 300 toys for distribution in 4-County’s service area.


“This is a great Christmas project,” said 4-County Senior Communications Coordinator Brad Barr. “We’re always excited to participate in our annual Toy Drive. A lot of children identified by Salvation Army wouldn’t have the same Christmas experience without the help of this charitable organization and organizations like 4-County.




Again, the deadline for dropping o toys is Dec. 13. Call Barr at 1-800-431-1544 for more information about the annual Toy Drive project. (Note: Special arrangements to pick up toy donations can also be made by calling Barr.)




Two new employees have joined the 4-County Electric Power Association team.
Carlee McAdams has joined the co-op as a member service representative. She is working in the Starkville o ce.
Carlee and her husband, Tyler, live in Caledonia. They have two dogs: Millie (a miniature Poodle and Shih Tzu mix) and River (a Black Labrador retriever).
Prior to 4-County, she worked as an insurance representative for The Gri n Center for Cosmetic Surgery.
In her spare time, she enjoys spending time with Tyler and reading.
Jacob Harrison of Steens has joined the 4-County team as a Pre-Apprentice Lineman. He will work on Tim Adkins’ Heavy Construction Crew, based at the co-op’s Corporate Center.
Prior to 4-County, Jacob worked as an Operator for Sumter Utilities in South Carolina. He is a graduate of East Mississippi Community College’s Lineman Training School. Jacob also attended Northwest Community College. In his spare time, he enjoys hunting and fishing.
Welcome to the 4-County team, Carlee and Jacob!















Seventeen of the best and brightest young leaders our state has to o er recently graduated from the prestigious 4-County Electric Power Association Cooperative University.
The high school juniors met at the co-op’s corporate center Nov. 5, vying for the opportunity to become 4-County Cooperative Youth Leadership delegates — representing the co-op on local, state and national levels. The program is an annual series of interviews and team building exercises.
Four high school juniors were selected to represent the cooperative as delegates at the 2025 Cooperative Leaders Workshop, sponsored by the Electric Cooperatives of Mississippi, in Jackson, Feb. 26-28, 2025.
Armando Dunand, a student at New Hope High School, was the firstplace winner. There was a tie for second place. Carey Beth Honnoll, a student at Starkville High School, was a second-place winner. Bes Sumrall, a student at Caledonia High School, also claimed secondplace honors. Hayes Carver, a student at Starkville Christian School, took home third place.

In addition to participating in the Youth Leadership Workshop, the students will travel to Washington, D.C., for the National Rural Electric Cooperative Association’s Youth Tour of the Capital, June 14-20.
Other students participating in the 4-County program, selected as winners for their respective schools, were Brayden Shelton of Heritage Academy, Jane DeSantis of Oak Hill Academy, Koleigh Gri n of French




David Easterling of Columbus Christian Academy, Raynee Lucas of Choctaw County High School, Anna McHann of East Webster High School, Tyler Bauer of Hebron Christian School, Anthony Givens of West Lowndes High School, Danika King of Victory Christian Academy, Rebekah Schilling of Starkville Academy, Kyla Drummond of Golden Triangle Early College High School, and Cloe Cox of West Point High School.
The 17 candidates competed for the opportunity to win the expensepaid trips. Nominated as the winners for his or her high school, each student completed an application reflecting school and extracurricular activities. A panel of three judges a liated with the Electric Cooperatives of Mississippi interviewed each of the students. The students were judged based on their participation in team-building programs.
Students also enjoyed a state legislative panel that included: Rep. Dana McLean, Sen. Charles Younger, Sen. Bart Williams and Rep. Andy Boyd. Engineers from the Tennessee Valley Authority discussed electric generation, and 4-County linemen presented a hot line demonstration.








Brad Barr, 4-County’s Cooperative Youth Leadership coordinator, applauded the e orts of all 17 candidates. “All of the candidates were outstanding. We can definitely look forward to a bright future if these young leaders are any indication. I believe they are. They were strong representatives of their families and schools,” Barr said.















































CARTHAGE: 601-267-5671 | PHILADELPHIA: 601-656-2601 | RANKIN: 601-829-1201 | SEBASTOPOL: 601-625-7422





In accordance with the laws of the State of Mississippi and the bylaws of the Association, four directors will be elected for three year terms. Members will elect one director from Leake County, one director from Neshoba County, one director from Newton County, and one minority member-at-large.


(a) It shall be the duty of the Board to appoint, not less than sixty (60) days nor more than ninety (90) days before the date of a meeting of the members at which Board members are to be elected, a Committee on Nominations consisting of three (3) members who shall be selected from the given areas from which Board members are to be elected so as to insure equitable representation. No existing Cooperative employees, agents, o cers, directors or known candidates for director, and close relatives (as hereinafter defined) or members of the same household of existing Cooperative employees, agents, o cers, directors or known candidates for director may serve on such committees. The committee shall receive and consider any suggestion as to nominees submitted in writing by members of the Cooperative consistent with these bylaws. The committee, keeping in mind the principle of equitable representation, shall prepare a list of nominations for Board members, and submit its list to the Secretary not less than thirty (30) days nor more than sixty (60) days before the date of the annual meeting.
(b) Any fifty (50) or more members who are in good standing, are from the given area from which a Board member is to be elected, and acting together, may nominate a Director candidate for the area by petition. Any such petition for nomination must be submitted on a form designated and provided by the Cooperative. Each member signing such petition shall place thereon the date of signing, address, account number and service location of the member. Such nominations made by petition, if any, shall be delivered to the Secretary not less than forty-five (45) days nor more than sixty (60) days before the date of the annual meeting. Such nominations shall be posted by the Secretary at
the same place where the list of nominations made by the Committee on Nominations is posted. A member may not make more than one (1) nomination by petition for each vacancy. If a member signs more than one petition for a director vacancy, then the signature of the member bearing the latest date of signing by the member will be considered and any previously dated signature by the member on any other petition(s) will be deemed invalid, null and void. If a member signs more than one petition on the same date, all signatures of the member bearing the same date of signing will be deemed invalid, null and void.

(c) The Secretary shall prepare and post at the principal o ce of the Cooperative at least twenty (20) days before the meeting a list of nominations for Board members. The Secretary shall be responsible for mailing with the notice of the meeting or separately, but at least ten (10) days before the date of the meeting, a statement of the number of Board members to be elected and the counties they will be elected from and represent, and the name and address of each of the candidates nominated by the Committee on Nominations or by petition.
A report from the Committee of Nominations, along with proxies, ballots and other annual meeting information will be mailed to members in February 2025. As a member-owner of Central Electric Power Association, you have a right to participate in the annual meeting to hear the latest cooperative news and to elect the board of directors. Mark your calendar for March 18, 2025, and plan to attend Central Electric’s annual meeting at the Carthage Coliseum on Highway 16 in Carthage.



















To report an outage, please visit www.centralepa.com and click on Report An Outage, call 601-267-3043, or text the word OUT to 866-846-5671 if you are enrolled in the outage texting service. A dispatcher is on duty 24 hours a day, 7 days a week.

Central Electric Power Association will be closed Dec. 24 and 25 for Christmas and Jan. 1 for New Year’s.


































Brian Long, Central Electric General Manager, presents plaques to Jim Caldwell and Thomas Gri n.














































Aby Miranda Boutelle
Let’s start with cooking your meal. Your electric oven is typically the highest-wattage appliance in the kitchen. Yet, people usually don’t turn their ovens on for long periods of time. Assuming an average oven wattage of 3,000 and an average cost of $0.16 per kilowatt-hour, according to the United States Energy Information Administration, it costs $0.48 an hour. Let’s say you use your oven for four hours to make a special meal. That’s less than $2 of electricity. While that may not seem like a big deal now, operating your oven for four hours every day is $700 a year.
Using smaller appliances instead of your oven can help you save. A slow cooker uses between 100 and 450 watts, which is significantly less than an electric oven at 2,000 to 5,000 watts. That means you can use a slow cooker for a longer period and still use less energy.
Opt for your microwave or toaster oven to reheat or cook smaller items. The microwave uses significantly less energy than the oven. A toaster oven uses about half the energy of a conventional oven, according to Energy Star®.
You also want to avoid turning on your oven and leaving the door open to heat your home. This can break your oven and be a safety hazard, especially with gas ovens that can cause carbon monoxide buildup.
When cooking on the stovetop, match the pot or pan size to the burner. Lids help your pots retain heat, which cooks food faster and wastes less heat. Keep your stovetop clean to ensure the appliance heats evenly.
If you’re looking to upgrade your stovetop, consider switching to an induction cooktop. It uses an electromagnetic field below the surface to heat pots and pans directly. This provides more precise heat, faster cook times and higher e ciency. It can also improve the air quality in your home when compared to a gas cooktop.
In my experience, people like to gather in the kitchen during parties. To avoid overheating your guests in a room that has a hot oven, turn your thermostat down a few degrees before guests arrive.
Next, let’s look for refrigerator savings. The gaskets on your refrigerator doors should make a tight seal to keep in cold air. Make sure you clean and maintain them or replace them if necessary. Don’t let frost build up
The holiday season brings opportunities to enjoy meals with friends and family, leading to spending more time in the kitchen. Whether hosting a few or a crowd, consider making new energy e ciency traditions this year with these tips to manage your energy use.
in the freezer, which can decrease e ciency and make your freezer work harder to maintain a balanced temperature.
Wait until food cools before putting leftovers in the fridge. Putting hot food in the refrigerator results in more energy used to cool it down. Aim for about 30 minutes of cool time. Perishable food should be refrigerated within two hours after it is cooked, according to the United States Department of Agriculture.

When shopping for new kitchen appliances, look for the Energy Star® logo. Energy Star® certification indicates the appliance is optimized for e ciency and energy savings, while also providing improved performance, quality, and durability.
Setting your refrigerator colder than needed wastes energy. The U.S. Department of Energy recommends 37 degrees for the refrigerator and 0 degrees for the freezer. Use an appliance thermometer to monitor the temperature.
When it comes to cleanup, run full loads of dishes in the dishwasher — being careful not to block any moving parts. Use eco mode if your dishwasher has that setting. If you are in the market for new appliances, select Energy Star® models.
Whatever you choose to cook or how you cook it, keep in mind these simple tips to make your kitchen more e cient and save energy this holiday season.
Miranda Boutelle is the chief operating o cer at E ciency Services Group in Oregon, a cooperatively owned energy e ciency company.

























by Qua’Shara Monix

















While Christmas can be magical, it often brings stress as people try to meet high expectations, juggle finances, and manage busy schedules. For starters, there’s the pressure of finding the “perfect” gifts. The hunt for meaningful presents can turn into hours of shopping, both in stores and online, sometimes followed by worry over budgets and overspending.
Then, there’s the stress of holiday gatherings. Planning and hosting family events, from the decorations to the meals, can feel overwhelming, especially if you’re aiming to recreate cherished traditions or meet the expectations of family members. There can also be an underlying anxiety if family dynamics are tense or if certain relatives don’t get along, making the “joyful” part of the season a bit strained.
Time management also becomes a challenge. Balancing work, holiday tasks, travel, and family obligations can make the weeks leading up to Christmas feel like a nonstop marathon. The calendar fills quickly with parties, school events, and community gatherings, leaving little time to simply relax and enjoy the season. And with holiday travel, there’s often the added stress of packed airports, winter weather delays, and navigating hectic roads.
For many, there’s also an emotional side to the holiday stress. Christmas brings memories and reflections, sometimes highlighting loved ones who aren’t there to celebrate, which can bring a layer of sadness and longing. In these cases, it’s easy to feel both the joy and the emptiness that come with cherished memories and missing traditions.
All in all, Christmas stress can stem from trying to make everything “just right,” whether it’s through perfect gifts, decorations, food, or family time.


However, there’s always Christmas morning, which can feel like waking up in a world where magic exists. The first hint of dawn casts a soft, warm glow, and you can feel a gentle excitement in the air. It’s still and quiet, except for maybe the subtle sound of someone moving around which could be a parent starting co ee. The smell of pine, cranberry, and maybe a hint of cinnamon and baked apples floating around, making everything feel festive and homey.
You walk through the house to see the Christmas tree lights twinkling, casting colorful reflections in the room. Wrapped presents sit under the tree, each with a di erent story of anticipation. There’s a comfort in knowing everyone you love will soon be there together, sharing laughs, traditions, and meals. Whether it’s the simple joy of wearing cozy pajamas all morning, unwrapping a gift you’ve been hoping for, or just sitting back and watching others smile, Christmas morning has a way of filling you with warmth and gratitude.
It’s a feeling mixed with joy and contentment, a unique blend of old memories and new beginnings that leaves you feeling full of love and wonder. It makes you appreciate small moments, family traditions, and the happiness that comes from giving and togetherness. Finding balance and focusing on the moments of joy and connection can help make this season feel more manageable and meaningful. Take time to recognize the daily moments that bring us Peace, Love, Happiness and really enjoying the root of your delight. You’re only here for a short visit. Don’t hurry. Don’t worry. Be sure to stop and smell the flowers along the way.
Wishing you a Merry Christmas and Happy New Year from Coahoma Electric Power Association.




Coahoma Electric Power Association will hold its Annual Meeting of the Membership at 10 a.m. Thursday, Feb. 13, 2025, at Coahoma Electric’s Headquarters multipurpose room at 3355 Rudyard-Jonestown Rd, Coahoma, MS 38617.
This new location is approximately 1 mile north of Coahoma County Airport on Highway 61.
The following is an excerpt from the association’s bylaws pertaining to the Annual Meeting of the Membership.
• Section 3.01. Annual Meeting.


For the purposes of electing Directors, hearing and passing upon reports covering the previous fiscal year, and transacting such other business as may properly come before the meeting, the annual meeting of the Members shall be held on the second Thursday of February of each year, at such place in Coahoma County, Mississippi, and beginning at such hour, as the Board of Directors shall, from year to year, fix; PROVIDED, that, for cause su cient, the Board of Directors may fix a di erent date for such annual meeting not more than thirty (30) days prior or subsequent to the day otherwise established for such meeting. Failure to hold the annual meeting at the designated time and place shall not work a forfeiture or dissolution of the Association.
• Section 3.02. Special Meetings.
Special meetings of the Members may be called by a majority of the Board of Directors, or upon written petition submitted to the Board of Directors signed by at least three hundred (300) Members; any such petition(s) shall be submitted on forms provided by the Association, and the same shall be signed, completed and verified in the same manner as are petitions submitted under Section 4.04 of these Bylaws. Special meetings shall be held at such place within Coahoma County, Mississippi, on such date, and at such hour as the Board of Directors shall fix and determine, and the Association’s Secretary shall cause notice of any such meetings to be given as hereinafter provided.
• Section 3.03. Notice of Members’ Meetings.
Written or printed notice stating the place, day and hour of the meeting and, in the case of a special meeting or of an annual meeting at which business requiring special notice is to be transacted, the purpose or purposes of the meeting shall be delivered to each Member not less than fifteen (15) days nor more than twenty-five (25) days prior to the date of the meeting, either personally, by mail, or electronically, by or at the direction of the Association’s Secretary, or by the directors or members calling the meeting. Written notice of any meeting at which the Association’s certificate of incorporation will be voted on by the Members must be sent to the Members at least

thirty (30) days prior to the date of the meeting, and shall identify and describe the purpose of the amendment. If Directors are to be elected at such meeting, the notice of Members’ meeting shall include a statement of the members of the Board of Directors to be elected as provided in Section 4.04. Unless specified in such notice of meeting, no matter may be acted upon at such meeting. If mailed, such notice shall be deemed to be delivered when deposited in the United States mail, addressed to the Member at his or her address as it appears on the records of the Association, with postage thereon prepaid. The failure of any Member to receive such notice shall not invalidate any action which may be taken by the Members at any such meeting.
• Section 3.04. Quorum.
Three hundred (300) Members shall constitute a quorum at any regular or special meeting of Members. This number shall be arrived at by adding the number of Members present in person at the meeting to the number of Members represented at that meeting by valid proxies filed as provided by these Bylaws. If less than a quorum is present at any meeting of Members, the o cer of the Association who is presiding at the meeting may, at the time stated in the notice and without a motion, declare the meeting adjourned and closed or he may hold the meeting open for not longer than thirty (30) minutes to see if a quorum is present within that time; and the meeting shall automatically be adjourned and closed if a quorum shall not be present at the end of said thirty (30) minute period. The Members present at a meeting at which a quorum is not present shall not have the power to take any kind of action, including, but not by way of limitations, adjourning said meeting to another time or place.
• Section 3.05. Voting.
Each Member who is not in a status of suspension, as provided for in Section 2.01, shall be entitled to only one vote upon each matter submitted to a vote at any meeting of the Members. A Member may vote at any such meeting either in person or by proxy. At a meeting of the Members where Directors are to be elected, all Members present in person or by proxy may cast one (1) vote for each Director to be elected; each Member may vote his or her own vote plus those proxies executed in such Member’s favor, pursuant to Section 3.06 and 3.07 of these Bylaws. Voting by Members other than Members who are natural persons shall be allowed upon the presentation to the
Association, prior to or upon registration at each Member meeting, of satisfactory evidence entitling the person presenting same to vote. At all meetings of the Members, all questions shall be decided by a majority of the Members voting thereon, except as otherwise provided by law or by the Association’s Certificate of Incorporation or these Bylaws or any amendment(s) thereto. Members may not cumulate their votes.
• Section 3.06. Proxies.
At all meetings of the Members, a Member may vote by proxy executed in writing and signed by the Member, subject to the provisions hereinafter set forth, provided, however, any Member intending to vote by proxy must file the executed proxy at the Association’s headquarters by the close of business on the later of the Monday preceding the annual or special meeting or three (3) business days prior to such meeting. A Member may personally deliver his or her proxy to the said o ces of the Association or mail the proxy by United States Mail, postage prepaid, addressed to the Secretary, Coahoma Electric Power Association, P. O. Box 188, Lyon, Mississippi, 38645. If the proxy is sent by mail, the date of its receipt in the Association’s o ce at the above address shall be its filing date. The proxy must have entered thereon the name and account number of the member appointed to vote the proxy. No proxy shall be voted at any meeting of the Members unless it shall designate the particular meeting at which it is to be voted, and no proxy shall be voted at any meeting other than the one so designated, or any adjournment of such meeting. No proxy shall be voted by anyone except a Member. A Member may appoint any other individual Member to vote his or her proxy, or a Member may appoint the individual members of the Board of Directors, collectively, to vote said proxy. No Member shall vote as proxy for more than fifty (50) Members at any meeting of the Members. In the event an individual Member is appointed to vote as proxy for more than fifty (50) other Members, such proxies in excess of fifty (50) shall be assigned to the Board of Directors for voting; and the proxies so assigned and those proxies appointing the individual members of the Board of Directors shall be voted according to the will of a majority of the Board of Directors. The presence of a Member at a meeting of the Members shall revoke a proxy theretofore executed by that Member, and such Member shall be entitled to vote at such meeting in the same manner and with the same e ect as if the proxy had not been executed. In case of a joint membership, a proxy may be executed by either spouse. The timely presence of either spouse at a meeting of the Members shall revoke a proxy theretofore executed by either of them and such joint Member (or Members) shall be entitled to vote at such meeting in the same manner and with the same e ect as if a proxy had not been executed. A standard proxy form shall be used which identifies the Member by name and Member number, in order to assure authenticity and facilitate the tabulation of votes. If the proxy form of a Member is
lost, stolen, or destroyed, the Association shall furnish such Member with a replacement proxy form upon request, provided that the Member executes a revocation of the lost, stolen or destroyed form, to be witnessed by an employee of the Association. Blank proxy forms will not be distributed in bulk to any Member. Designation of proxies shall be upon forms prescribed by the Board of Directors and furnished by the Association and no other forms shall be recognized or accepted.
• Section 4.04. Committee on Nominations.
Thursday, Feb. 13, 2025 at 10 a.m.
Coahoma Electric’s Headquarters • Coahoma, MS
Robert A. Boyce
(a) It shall be the duty of the Board of Directors to appoint, no less than forty (40) calendar days nor more than ninety (90) calendar days before the date of the meeting of the Members at which Directors are to be elected, a Committee on Nominations consisting of not less than five (5) nor more than eleven (11) Members who shall be selected with consideration being given to provide geographic representation of the Association’s service area. No existing Association employees, agents, o cers, Directors or known candidates for Director, and close relatives (as hereinafter defined) or members of the same household of existing association employees, agents, o cers, Directors or known candidates for Director may serve on such committee. The Committee on Nominations shall receive and consider any suggestion as to nominees submitted by Members. The Committee on Nominations shall meet at a time and place set by the Board of Directors. The Committee on Nominations shall prepare and post at the principal o ce of the Association at least thirty-five (35) calendar days before the meeting a list of nominations for Directors. The Secretary must mail with the notice of the meeting or separately a statement of the number of Directors to be elected and the names and addresses of the candidates nominated by the Committee on Nominations.
(b) Nominations By Petition. Any fifty (50) Members acting together may make a nomination by petition and the Secretary shall post such nomination at the same place where the list of nominations by the Committee on Nominations is posted. Any petition for nomination shall be submitted on a form designated and provided by the Association. Each Member signing such petition shall place thereon the date of signing, address and account number of the Member. The Secretary shall mail with the notice of the meeting or separately a statement of the number of board members to be elected and the names of candidates nominated by the committees and the names of candidates nominated by petition, if any. Nominations made by petition, if any, received by the close of business at least 90 calendar days before the annual meeting shall be included on the o cial ballot. No petition may contain more than one nominee.
(c) Notwithstanding anything in this Section, failure to comply with any of the provisions of this Section shall not a ect in any manner whatsoever the validity of any election of Directors.
Considering an electric vehicle? Use this guide as you consider vehicle options.
Battery Electric Vehicle (BEV):
Fully powered by an electric battery; no gas-powered components.
BEV: 110-300 miles *full battery
Electric Vehicle (PHEV):
Contains an engine, electric motor and large battery; can operate in electric-only mode, engine-only mode or hybrid mode (battery and gas).
PHEV: 15-60 miles on battery power *full battery (PHEVs can run on battery and/or gas power)
Level 1:
• 110-volt service
• 2-5 miles of range per hour of charging
• Typically does not require electrical upgrades
Level 2:
• 240-volt service
• 10-30 miles of range per hour of charging
• Faster than level 1
• May require electrical upgrades
Hybrid Electric Vehicle (HEV):
Low-emission vehicles; electric motor assists gas-powered engine. Fully powered by gasoline (no charging).
• Public charging options near you
• Federal, state and local financial incentives
• Battery warranties
• Potential changes to auto insurance












Our o ces will be closed Tuesday, Dec. 24, and Wednesday, Dec. 25, 2024, in observance of Christmas. We will reopen on Thursday, Dec. 26, 2024.
Our o ces will be closed Wednesday, Jan. 1, in observance of New Year’s Day. We will reopen on Thursday, Jan. 2, 2025.




































Coast Electric wants you to reduce your energy use and see savings on your energy costs. Each month, you will have an opportunity to register to win a prize that will help you reduce the energy consumption in your home. Visit www.coastelectric.coop or scan the QR code to enter. It only takes a few seconds, and you could win a prize that helps you save!




On behalf of Coast Electric and CoastConnect employees, I wish you a merry Christmas! Whether we are powering the lights on your tree, an oven full of pecan pies, or providing high-speed internet service for all the new high-tech gifts under your tree, we like knowing that our services play a role in making your days merry and bright this holiday season. Our wish for each of you is that you can spend time surrounded by your loved ones, thinking back on all the happy moments you’ve had in 2024 and looking forward to the new opportunities 2025 will bring. We will be looking at opportunities to fulfill our mission to you and make our community a better place to live, work and play. Merry Christmas and Happy New Year!

by Ron Barnes
President and CEO















Congratulations to LaShon Sellers, the winner of our October Reduce Your Use prize!






















Coast Electric and CoastConnect o ces will be closed Tuesday and Wednesday, Dec. 24-25, for the Christmas holidays and Wednesday, Jan. 1, for New Year’s.
Coast Electric dispatchers will be on duty, and crews will be on call. If you need to report an outage, you can text us at 228-338-4644 if you have a mobile number associated with your account. You can also report your outage on coastelectric.coop, use our CE on the Go app, or call 877-769-2372.
For 24/7 tech support with CoastConnect, chat online at www.CoastConnect.com or call 877-969-3884.






The Annual Meeting is one of the most important nights of the year for your cooperative. Besides allowing us to conduct the business of electing board members to represent you, we also spend time getting to know you and learning how we can fulfill our mission of improving your quality of life. We appreciate everyone who attended our meeting, registered by proxy and watched the meeting online.
At Coast Electric’s Annual Meeting on Nov. 7, three members were elected as directors for Position One and received the following votes:
James Baldree – 9,796 votes
Charles Lopez – 9,796 votes
Richard Dossett - 9,796 votes
Coast Electric President and CEO Ron Barnes announced at the cooperative’s 2024 Annual Meeting that the cooperative will retire $6,010,046 in capital credits to its members. Checks are scheduled to be mailed to eligible current and former members in December. By the end of 2024, Coast Electric will have paid more than $99 million in capital credit retirements to current and former members.
Member-owned cooperatives are not-forprofit organizations operated for the benefit of their members. In general, if there are revenues from electric services in excess of operating costs and expenses, those funds are credited to a member’s capital account based on their patronage. Such funds, which are also called ‘capital credits,’ are the life blood that enables cooperatives to satisfy the future growth and power needs of its members.
Capital credits represent a critical source of equity for Coast Electric. Since a cooperative’s members are also the people it serves, capital credits reflect each member’s ownership in, and contribution of capital to the cooperative.
Each member is allocated capital credits based on how much energy they obtain from the cooperative. The more energy a member purchases, the greater the amount of capital credit allocated to the member’s account. At the end of each year, Coast Electric subtracts operating costs and expenses from operating revenue collected during the year. This di erence is called margins, which are allocated to the members on the basis of patronage.
$6,010,046 IN CAPITAL CREDITS RETIRED TO THE MEMBERS
Any member who has purchased electricity from Coast Electric during the time being retired is eligible to receive a capital credit check. The minimum retirement check that will be mailed to members is $10. If a member’s retirement is under the $10 minimum, the allocated capital credits will remain in their account until the retired balance exceeds $10. At that point, a check will be distributed during the next retirement period.
Members who have questions about their capital credit accounts may visit https://coastelectric.coop/capital-credits/.
Congratulations to our members who won credits on their electric bills by either attending our Annual Meeting or registering online, in one of our o ces or by mail.
$100 Bill Credit Winners
James Pulse
Jilean Denee
Michael Dickinson
Gertha Lee
Roger Mason
Riley Ann Norman
Susan Simmons
Gwendolyn Smith
Brianna West
Marilyn Herndon
$50 Home Depot Gift Card
Cammie Peterson
Ida Brown
Attendance Grand Prize Winners
$250 Coast Electric Bill Credit • Fred Knight
$500 Coast Electric Bill Credit • Daniel Beavers
Nell Johnson
Ronald Thompson
Valerie Hendry
Twyla Sue Jordan
Burgetown Church
$1,000 Coast Electric Bill Credit • Barbara Zitzmann
Proxy Registration Grand Prize Winners
$250 Coast Electric Bill Credit • Julie Smith
$500 Coast Electric Bill Credit • Leonard Schwab, Jr.
$1,000 Coast Electric Bill Credit • Mary Ann Gambino












DID YOU MISS IT?





No worries! Our meeting was recorded and is available on our YouTube channel. Search for Coast Electric.


























Aby Miranda Boutelle
Let’s start with cooking your meal. Your electric oven is typically the highest-wattage appliance in the kitchen. Yet, people usually don’t turn their ovens on for long periods of time. Assuming an average oven wattage of 3,000 and an average cost of $0.16 per kilowatt-hour, according to the United States Energy Information Administration, it costs $0.48 an hour. Let’s say you use your oven for four hours to make a special meal. That’s less than $2 of electricity. While that may not seem like a big deal now, operating your oven for four hours every day is $700 a year.
Using smaller appliances instead of your oven can help you save. A slow cooker uses between 100 and 450 watts, which is significantly less than an electric oven at 2,000 to 5,000 watts. That means you can use a slow cooker for a longer period and still use less energy.
Opt for your microwave or toaster oven to reheat or cook smaller items. The microwave uses significantly less energy than the oven. A toaster oven uses about half the energy of a conventional oven, according to Energy Star®.
You also want to avoid turning on your oven and leaving the door open to heat your home. This can break your oven and be a safety hazard, especially with gas ovens that can cause carbon monoxide buildup.
When cooking on the stovetop, match the pot or pan size to the burner. Lids help your pots retain heat, which cooks food faster and wastes less heat. Keep your stovetop clean to ensure the appliance heats evenly.
If you’re looking to upgrade your stovetop, consider switching to an induction cooktop. It uses an electromagnetic field below the surface to heat pots and pans directly. This provides more precise heat, faster cook times and higher e ciency. It can also improve the air quality in your home when compared to a gas cooktop.
In my experience, people like to gather in the kitchen during parties. To avoid overheating your guests in a room that has a hot oven, turn your thermostat down a few degrees before guests arrive.
Next, let’s look for refrigerator savings. The gaskets on your refrigerator doors should make a tight seal to keep in cold air. Make sure you clean and maintain them or replace them if necessary. Don’t let frost
The holiday season brings opportunities to enjoy meals with friends and family, leading to spending more time in the kitchen. Whether hosting a few or a crowd, consider making new energy e ciency traditions this year with these tips to manage your energy use.
build up in the freezer, which can decrease e ciency and make your freezer work harder to maintain a balanced temperature.
Wait until food cools before putting leftovers in the fridge. Putting hot food in the refrigerator results in more energy used to cool it down. Aim for about 30 minutes of cool time. Perishable food should be refrigerated within two hours after it is cooked, according to the United States Department of Agriculture.

When shopping for new kitchen appliances, look for the Energy Star® logo. Energy Star® certification indicates the appliance is optimized for e ciency and energy savings, while also providing improved performance, quality, and durability.
Setting your refrigerator colder than needed wastes energy. The U.S. Department of Energy recommends 37 degrees for the refrigerator and 0 degrees for the freezer. Use an appliance thermometer to monitor the temperature.
When it comes to cleanup, run full loads of dishes in the dishwasher — being careful not to block any moving parts. Use eco mode if your dishwasher has that setting. If you are in the market for new appliances, select Energy Star® models.
Whatever you choose to cook or how you cook it, keep in mind these simple tips to make your kitchen more e cient and save energy this holiday season.
Miranda Boutelle is the chief operating o cer at E ciency Services Group in Oregon, a cooperatively owned energy e ciency company.








by Jennah Denney















As the holiday season approaches and the days grow colder, you may be considering ways to stay cozy while also managing home energy use.
One of the best ways to make your home more energy e cient is by choosing products with the Energy Star® label. But what exactly does that label mean, and how can it benefit you?
Energy Star® is a program by the U.S. Department of Energy (DoE) and the Environmental Protection Agency (EPA) to help consumers identify energy e cient products that save money and reduce environmental impact.

Products that earn the Energy Star® label must meet strict guidelines for energy e ciency, performance, and cost e ectiveness. Here’s how the process works:
The product must be more energy e cient than typical models. This helps you save on energy bills by using less electricity while still providing the same performance.
The product must be tested in EPA-recognized labs, following standardized procedures. These tests ensure the product meets all energy e ciency and performance requirements.

Once tested, the product’s data is reviewed by a third-party certification body to verify it meets the set standards. This ensures that only the best products receive the Energy Star® label.


Even after a product is certified, the EPA conducts “o -the-shelf” testing on random samples of Energy Star® products to ensure they continue to meet the required standards. If a product fails to meet the performance requirements during verification testing, it can be disqualified from the Energy Star® program. The EPA has clear procedures for handling such disqualifications to maintain the integrity of the label.
To browse products that have earned the Energy Star® label, visit https://www.energystar.gov.







Whether you’re upgrading your refrigerator, replacing light bulbs, or purchasing new electronics, the blue Energy Star® label is your assurance that the product has passed all energy e ciency tests. It’s easy to spot and can be found on products ranging from small and major appliances to electronics.
Many large appliances, such as washing machines and clothes dryers, include a yellow Energy Guide label that provides estimated energy use. Comparing these labels can help you determine how much you’ll save with an Energy Star® model compared to a standard model.

While Energy Star® products can cost a little more upfront, their energy savings over time will often cover the di erence. They help reduce your household energy consumption, which could translate to lower utility bills.
As a member of an electric cooperative, choosing energy e cient products benefits not only you but also our entire community. When co-op members use less energy, it lowers overall electricity demand, helping to stabilize rates and reduce costs for everyone.
As you shop for appliances, electronics, or other home equipment this holiday season, look for the Energy Star® label. Whether it’s a new washing machine or energy e cient lighting options, these products are a simple and e ective way to save money and lower energy use.








QHow can I save in the kitchen during the most expensive time of the year?



AThe holiday season brings opportunities to enjoy meals with friends and family, leading to spending more time in the kitchen. Whether hosting a few or a crowd, consider making new energy e ciency traditions this year with these tips to manage your energy use.


by Miranda Boutelle
Let’s start with cooking your meal. Your electric oven is typically the highest-wattage appliance in the kitchen. Yet, people usually don’t turn their ovens on for long periods of time. Assuming an average oven wattage of 3,000 and an average cost of $0.16 per kilowatt-hour, according to the United States Energy Information Administration, it costs $0.48 an hour. Let’s say you use your oven for four hours to make a special meal. That’s less than $2 of electricity. While that may not seem like a big deal now, operating your oven for four hours every day is $700 a year.
Using smaller appliances instead of your oven can help you save. A slow cooker uses between 100 and 450 watts, which is significantly less than an electric oven at 2,000 to 5,000 watts. That means you can use a slow cooker for a longer period and still use less energy.
Opt for your microwave or toaster oven to reheat or cook smaller items. The microwave uses significantly less energy than the oven. A toaster oven uses about half the energy of a conventional oven, according to Energy Star®.
You also want to avoid turning on your oven and leaving the door open to heat your home. This can break your oven and be a safety hazard, especially with gas ovens that can cause carbon monoxide buildup.
When cooking on the stovetop, match the pot or pan size to the burner. Lids help your pots retain heat, which cooks food faster and wastes less heat. Keep your stovetop clean to ensure the appliance heats evenly.
If you’re looking to upgrade your stovetop, consider switching to an induction cooktop. It uses an electromagnetic field below the surface to heat pots and pans directly. This provides more precise heat, faster cook times and higher e ciency. It can also improve the air quality in your home when compared to a gas cooktop.
In my experience, people like to gather in the kitchen during parties. To avoid overheating your guests in a room that has a hot oven, turn your thermostat down a few degrees before guests arrive.
Next, let’s look for refrigerator savings. The gaskets on your refrigerator doors should make a tight seal to keep in cold air. Make sure you clean and maintain them or replace them if necessary. Don’t let frost build up in the freezer, which can decrease e ciency and make your freezer work harder to maintain a balanced temperature.
In my experience, people like to gather in the kitchen during parties. To avoid overheating your guests in a room that has a hot oven, turn your thermostat down a few degrees before guests arrive.
Wait until food cools before putting leftovers in the fridge. Putting hot food in the refrigerator results in more energy used to cool it down. Aim for about 30 minutes of cool time. Perishable food should be refrigerated within two hours after it is cooked, according to the United States Department of Agriculture.
Setting your refrigerator colder than needed wastes energy. The U.S. Department of Energy recommends 37 degrees for the refrigerator and 0 degrees for the freezer. Use an appliance thermometer to monitor the temperature.
When it comes to cleanup, run full loads of dishes in the dishwasher — being careful not to block any moving parts. Use eco mode if your dishwasher has that setting. If you are in the market for new appliances, select Energy Star® models.
Whatever you choose to cook or how you cook it, keep in mind these simple tips to make your kitchen more e cient and save energy this holiday season.
Miranda Boutelle is the chief operating o cer at E ciency Services Group in Oregon, a cooperatively owned energy e ciency company.




Considering an electric vehicle? Use this guide as you consider vehicle options.
Battery Electric Vehicle (BEV):
Fully powered by an electric battery; no gas-powered components.
BEV: 110-300 miles *full battery
Electric Vehicle (PHEV):
Contains an engine, electric motor and large battery; can operate in electric-only mode, engine-only mode or hybrid mode (battery and gas).
PHEV: 15-60 miles on battery power *full battery (PHEVs can run on battery and/or gas power)
Level 1:
• 110-volt service
• 2-5 miles of range per hour of charging
• Typically does not require electrical upgrades
Level 2:
• 240-volt service
• 10-30 miles of range per hour of charging
• Faster than level 1
• May require electrical upgrades



Hybrid Electric Vehicle (HEV):
Low-emission vehicles; electric motor assists gas-powered engine. Fully powered by gasoline (no charging).
• Public charging options near you
• Federal, state and local financial incentives
• Battery warranties
• Potential changes to auto insurance

































As the year draws to a close and we enter the Christmas season, I’m thankful for the many opportunities we’ve had to make an impact on our local communities. The principle of “concern for community” has long been a part of who we are, and this year, we were able to take advantage of even more opportunities to serve others, uplift families, and bring smiles to faces across our region. There’s something especially meaningful about entering December with the knowledge that we’ve made a di erence, together.
We were recently honored by the Jones County Chamber of Commerce with the Community Champion Award, which honors an organization that has made an extraordinary impact in our community, leaving a lasting legacy. Impacting our community is something we will continue to strive to do. Our goal isn’t to win awards; it is to continue to impact the lives of the people who live here.
Throughout the year, we supported numerous causes, always with the hope of strengthening and uniting our community. Here’s a look back at some of the many ways we came together for the greater good:
• Through candy bar sales, we raised $2,162 for Cherished Hearts, supporting their work within our community with assisting abused children within the Pine Belt region.
• $2,000 was given to four volunteer fire departments across our system and to the Burn Foundation of America.
• $1,000 was donated to Children’s of Mississippi Hospital from our Easter Bunny photo fundraisers.
• This year’s charity golf tournament raised an incredible $15,600 to be shared with the Glory House and local programs that provide secret meals for kids who experience food insecurities.
• $7,700 was divided and donated to local food pantries, thanks to our members’ participation in our annual board election voting.
• $23,576 was donated to United Way through employee donations, further supporting a network of local initiatives.
• 225 backpacks filled with essential items were prepared for foster children, ensuring these children and foster families felt supported and valued.
• 18 school visits allowed us to reach out to students with vital electrical safety tips and insights into career opportunities within our industry.
• Our Energy Fairs helped members learn how to save on their bills and be more energy-conscious.
• Our annual Student Art Contest showcased the talents of young artists across our district.
• We provided donations to each school system across our system, helping to support local education.
• Our Cooperative Youth Leaders program continues to cultivate the next generation of community-minded leaders.
• We proudly partnered with Habitat for Humanity to build a ramp for a family who needed safe access into their home.
• When Hurricane Helene and Hurricane Milton struck, we stood by our fellow co-ops, lending support and resources to aid in the recovery e orts.
• Hosted multiple blood drives to support life-saving e orts within our community.
• Our peanut butter and jelly drive made its way to five di erent organizations.
• Our Stu a Bucket food drives provided nonperishable items for three food pantries in our area.
As we look toward the holidays, I’m reminded of a Winston Churchill quote: “We make a living by what we get, but we make a life by what we give.” Yes, Dixie Electric is a utility who provides electricity at a cost. That’s what we do. But we are also a group of people who want to make a di erence in the lives of the people in the communities we serve.
That’s who we are. We’re very appreciative of the opportunity. On behalf of our entire cooperative family, may your holidays be filled with joy, warmth, and the spirit of togetherness. We look forward to serving you with the same commitment in the coming year.









by Randy Smith General Manager











by Amanda Mills
On Saturday, Oct. 19, Dixie Electric held its 86th Annual Meeting at its headquarters in Laurel.
Opportunities for voting began online in late August and by mail-in balloting in September. It was a record-breaking year of voting, with more than 7,700 members voting in our annual board elections. Online voting has continued to grow in popularity, with our online voting totals increasing by 1,100 over last year.
In a continued tradition. for each vote cast or proxy submitted, Dixie Electric’s board of directors agreed to donate $1 to be divided equally
among the Christian Food Mission in Laurel, Petal Children’s Task Force, and the Samaritan Closet and Pantry in Waynesboro. Each of these beneficiaries will receive a donation of $2,600.
At the annual meeting, Robert Smith, Stan Pickering, and Faye Bonner were re-elected to serve on the board of directors. General Manager Randy Smith gave a brief overview of the cooperative, including the impressive progress of DE Fastlink. He also discussed the capital credit retirement and our mutual aid e orts and recapped our year of community service e orts.














































































been very busy participating in local career fairs, connecting with students, and showcasing the many roles that help our cooperative run smoothly.
While our hardworking linemen are often the most visible representatives of our cooperative, it's important for students to understand that we o er a diverse range of career opportunities. Alongside our dedicated linemen, we employ engineers who design and maintain our systems, customer service representatives who ensure our members are supported, IT specialists who keep our technology running, fiber technicians who keep us connected, accountants who manage our finances, and communication professionals, like myself, who help share our story with the community.
Engaging with students about these various roles gives them a broader understanding of the career paths they could take within our industry. Through this kind of outreach, we want them to see that there’s a place for their unique talents at Dixie Electric, whether it’s working hands-on in the field or communicating and strategizing behind the scenes.
I know firsthand how fulfilling this work can be. My own role allows me to not only inform and educate our members but also make a meaningful impact in my community. This industry needs creative thinkers, problem-solvers, and communicators just as much as it needs our dedicated skilled workers.
As we continue to participate in these career fairs, our goal is to help students envision themselves here, supporting our mission and advancing our community. Educating young people about the diverse opportunities in our field is a privilege, and I look forward to seeing how our message resonates with the next generation of leaders and innovators.



































DeKalb 601-743-2641 • Louisville 662-773-5741 • Quitman 601-776-6271 • Meridian / After-Hours Outages 601-581-8600
MEMBER OWNED. LOCALLY OPERATED. THAT’S THE COOPERATIVE DIFFERENCE.
A few weeks ago, I was walking up the aisle past one of my fellow church members when he stopped me. “I just want to tell you how good a job the EMEPA and EMC employees are doing for our community. You can tell they enjoy their work,” he said. It made my day, and I thanked him for sharing. Four days later, he went to be with our Lord. The lesson I took from that encounter is never to delay sharing an encouraging word with others.
Everywhere I go I run into people who want to talk about East Mississippi Electric Power Association. Conversations that start about broadband, power generation, artificial intelligence, electric vehicles, data centers, solar energy, or industrial needs always come back to how well our employees serve our members.
Our teams at EMEPA and East Mississippi Connect truly enjoy their work. It’s hard work, often done under challenging conditions, and requires years of education and training. For many, it’s more than just a career — it’s a way of life. Whether in communications, human resources, linework, right-of-way management, member services, accounting, engineering, or one of the many support roles across the cooperative, it takes us all to provide the high-quality service you expect.
When a member of EMEPA or subscriber of EMC walks through our doors, calls us, or reaches out on one of our digital platforms, our team works to meet their needs and provide the needed services. Field personnel communicate safety requirements and work to locate lines as conveniently as possible. Each day, our line crews are out constructing new services, maintaining the system proactively, and restoring power after disruptions.



This year, we were blessed to avoid extremely severe weather. Although we experienced some storms, saw more dead trees falling, and had some outages, we repaired lines and restored service quickly. We also sent employees to assist our neighbors in Florida after two hurricanes, living out the Cooperative Principle of “Cooperation Among Cooperatives.” Mutual aid agreements ensure that we have assistance when we need it and allow us to provide help to others in their times of need.
Strong organizations are built on strong foundations. Over the years, many dedicated people have built EMEPA, and it’s our responsibility to carry that legacy forward. As we look toward 2025, you can count on EMEPA and EMC to anticipate and plan for the future, carry out those plans a ordably and e ciently, and honor the trust you place in us.
Thank you to the employees who make EMEPA and EMC what our members and subscribers rely on. And thank you to each of you for the trust and friendships we’ve developed. May your Christmas be joyful, and may the New Year bring you prosperity and laughter.

by Randy Carroll
CEO — East Mississippi Electric Power Association


From our co-op family to yours, wishing you a happy holiday season and a joyous new year.
East Mississippi Electric Power Association will be closed Tuesday, Dec. 24, and Wednesday, Dec. 25, for Christmas and Wednesday, Jan. 1 , for New Year’s Day.


East Mississippi Electric Power Association’s Board of Directors is retiring more than $2.2 million in capital credits for the years 1993 and 1994.
The retirement amount is set by the board on a 30-year rotation and depends on the cooperative’s financial condition and strategic plan for growth and operations. The capital credits are among the many member benefits that set EMEPA apart.
EMEPA uses capital credits to invest in the operations of the cooperative, including purchasing bucket trucks, poles and wire, among other items. This reduces the need for loans and related expenses and benefits members by helping keep power costs low.
“As a not-for-profit electric cooperative, we belong to the communities we serve, so any excess revenues are shared back with the members,” said CEO Randy Carroll. “It is all part of what makes cooperative membership di erent.”
To learn more about Capital Credits, visit EMEPA.com/account/capital-credits.
On November 8, 2024, at the November meeting of the Board of Directors, Section 4.03 of the Bylaws was amended, by unanimous vote, with respect to director qualifications. Section 8.02 was also amended to allow EMEPA to require use of approved forms for capital credit assignment. Members may access the revised and amended Bylaws by logging into the Member Portal at EMEPA.com.


Join us in making this holiday season extra special for the children in our community! Any current East Mississippi Connect subscriber who donates a new, unwrapped toy will have a chance to win one of three Smart Stockings packed with incredible smart home gadgets!






Each Smart Stocking is stu ed with tech goodies like smart plugs, colorful smart light bulbs, Bluetooth speakers, Amazon Firesticks, Apple AirTags, and so much more! Just imagine lighting up your home with the magic of technology this Christmas season.
1. Donate a new, unwrapped toy — Drop it o at any EMEPA o ce location.
2. Deadline for donations: Friday, Dec. 13
3. Drawing date: Winners will be announced Monday, Dec. 16.

Your generosity brightens a child’s Christmas and gives you a chance to bring some smart magic to your own home. Let’s come together and make the holidays brighter!































From a “Life of a Lineman” demonstration to a hands-on safety presentation and a Q&A panel with state legislators, EMEPA’s recent Cooperative University o ered participants an in-depth look into the daily operations of an electric utility.
Hosted as part of EMEPA’s Cooperative Youth Leaders program, the event welcomed 11 student representatives from across east Mississippi for a guided tour of the cooperative’s headquarters. The students interacted directly with EMEPA employees, learning about the cooperative’s impact on the community.
Every high school in EMEPA’s service area is invited to nominate one junior student to join the program. Schools are encouraged to choose students based on academic achievement, school and community involvement, natural leadership qualities, and a desire to enhance their skills as future leaders.
“The Cooperative Youth Leaders program o ers local students a unique chance to observe our political process up close,” said Julie Boles, EMEPA’s director of marketing and communication. “Our aim is to educate students on the role of electric cooperatives, familiarize them with our state and national legislatures, and inspire them to grow as leaders and engage with their communities.”
Based on their performance in interviews and leadership skills demonstrated throughout the event, five students were selected to represent EMEPA at the February 2025 Cooperative Youth Leaders Workshop in Jackson. Organized by the Electric Cooperatives of Mississippi (ECM), this workshop will welcome over 80 students from across the state to explore state government and participate in leadership-enhancing activities.
In June 2025, these five students will travel to Washington, D.C., on an expense-paid, week-long trip, where they will visit historic monuments and memorials and meet with Mississippi’s senators and representatives.
“Over the years, EMEPA’s Cooperative Youth Leaders program has empowered hundreds of young leaders with the skills and knowledge to make a positive impact in their communities,” added Boles. “These exceptional students represent the core of EMEPA’s youth leadership network, and their achievements highlight the limitless potential of young people in east Mississippi.”







The 2024-2025 Cooperative University participants include:
Hayden Clark, Clarkdale High School*
Reese Parker, Enterprise High School
Chamber Lee Copeland, Kemper Academy*
RosEyunta Ott, Kemper County High School*
Chelsea Bibbs, Louisville High School
Isabella Collins, Northeast Lauderdale High School
Shandrea Odom, Quitman High School
Myles Coleman, Russell Christian Academy*
Dasia Crosby, Southeast Lauderdale High School
Lauren Skinner, West Lauderdale High School*
Carsen McAdory, Winston Academy
The National Rural Electric Cooperative Association (NRECA) sponsors the Youth Tour program nationally.
* Students selected to advance to the ECM Cooperative Leaders Workshop in Jackson and the NRECA Youth Tour in Washington, D.C.
Despite the busyness of the holidays, you can simplify your life, enhance your security and embrace the future of smart living this holiday season! Experience the magic of seamless connectivity with the East Mississippi Connect Wi-Fi Control App — where convenience meets innovation.
UNIVERSAL CONTROL:
Say goodbye to the chaos of multiple remotes and apps! With our app, you can control all your smart devices from one convenient interface.
EASY SETUP:
It's as simple as 1-2-3! Download the app, connect your devices and start managing them e ortlessly. No more complicated instructions or technical jargon.
SMART HOME HUB:
Transform your living space into a smart home. Control your lights,
thermostats, security cameras and more from anywhere, whether you're at home or on the go.
ENHANCED SECURITY: Worried about your network security? Our app o ers top-notch security features to protect your data and your privacy.
AUTOMATION:
Set schedules, create scenes and automate your devices to fit your lifestyle. Wake up to a warm, well-lit home or return to a cozy atmosphere after work.




























ENDLESS POSSIBILITIES:
Whether you have smart lights, locks, outlets or appliances, our app supports a wide range of devices from various brands.
CREATE A GUEST NETWORK:
In your EMC Wi-Fi app, click on Guest Network. Create a fun and memorable name for your guest network. Something like "HolidayHaven" or "FestiveWi-Fi" could be a great choice. Be creative! You can adjust settings or disable the guest network when it's no longer needed. By following these steps, you can provide a separate guest network for your loved ones during the holidays, ensuring a seamless and secure Wi-Fi experience while celebrating together.


























On the morning of Oct. 9, 10 Magnolia Electric Power linemen gathered for a quick photo before loading into trucks and driving to Florida.
This was the second group of MEP linemen to travel to Florida to help with power restoration e orts following another devastating hurricane in a short period of time. This group traveled to Clay Electric, headquartered in Keystone Heights, Florida, to help in the aftermath of Hurricane Milton.
The MEP linemen in Florida were Alex Fortenberry, Chad Moak, Matt Hamilton, Brett Abernathy, Kasy Jenkins, Corey Fletcher, Jacob Gill, Tanner Gunther, Logan Rushing, and Matt Lee.
The linemen worked to restore power to the members of Clay Electric from the day they arrived until Oct. 13, when they were released to travel home.
At one point the linemen found themselves using a boat to access an island to work on restoring power. They also waded in waist-high and chest-high water to get electricity restored to the Clay Electric members.

In an email from Clay Electric Cooperative Chief Operations O cer Bryan Gunter, he stated, “Thank you for all your help, noting these restoration e orts could not be completed successfully without your team. And please know these crews did not back down to any challenge, not even when they were put on the infamous and remote Drayton and Hog Islands.”
The Drayton and Hog Islands are located between Daytona and Gainesville, Florida, and can only be accessed by boat. The linemen had to climb the poles on the island to work on the powerlines.
By working with other electric cooperatives, MEP actively demonstrated Cooperative Principle No. 6 — Cooperation Among Cooperatives.
MEP Manager of Operations, Daniel Evans, added, “We take every opportunity we can to help our fellow electric cooperatives. We know firsthand how a hurricane can impact a power system, and the amount of help it takes to restore power after a major weather event.
“We also want to thank all our members who posted words of support on our Facebook account for our linemen to read. The prayers and words of encouragement mean a lot to our MEP employees and their families,” Evans said.



























Magnolia Electric Power welcomed 20 young leaders from across MEP’s service area Oct. 10 competing for two trips — one to a leadership workshop in Jackson and a second to a week-long, all-expense-paid trip to Washington, D.C.
Cooperative University is a one-day event which includes several learning elements about how electric co-ops work as well as leadership skills.
“We try to bring education along with fun leadership games to the students who attend,” said Manager of Member Services and Communications Lucy Shell.
“We were excited to have four of our state legislators attend. The students listened as Sen. Jason Barrett and Representatives Becky Currie,
Sam Mimms, and Daryl Porter spoke to them and then gave them a question-and-answer time,” Shell said.
The students who attended Cooperative University were Anna Claire “Ace” Fortenberry, Addison Lunsford, Brady Michael Durr, Bryce Prestridge, Caden Tyson, De’Breylon “Breylon” Lee, Dylan Collins, Eli McEwen, Emma Temple, Eva Mason, Hunter Smith, Lainey Sterling, Lauren Homesby, Meghan Richardson, Ny’Zyria Hogan, Quinterious Thompson, Reagan Bush, Reed Morgan, Terra Vining, and Thomas Baker.
The students were judged during the Cooperative University and at the conclusion of the event, 10 students moved forward in the competition to the interview round, which was held the next day.
In a two-day competition that began with Cooperative University and concluded with an interview session, four students out of 20 high school students were chosen to represent Magnolia Electric Power in the Electric Cooperatives of Mississippi (ECM), Cooperative Leaders Workshop in Jackson in February 2025 and the National Youth tour trip to Washington, D.C. in June 2025.
Twenty students were invited to attend the local competition. After the first day at Cooperative University where the students were judged on leadership skills, 10 students moved forward in the competition to the interview round.
The 20 nominees who began the competition were selected by their school counselors from schools in the Magnolia Electric Power service area,” said Lucy Shell, Magnolia Electric’s manager of member services and communications.
“Fifty percent of the participant’s score comes from Cooperative University participation and the other 50% comes from their interview held the second day.”
Following the interview process, four students scored high and were selected to attend the Leadership Workshop in Jackson and the trip to Washington, D.C.
The top four choices by the judges over the two-day period were Brady Michael Durr of Brookhaven Academy, Meghan
Richardson of Bogue Chitto, Lauren Hornesby of McComb High School, and Lainey Sterling of Parklane Academy.
Durr, Richardson, Hornesby, and Sterling will represent Magnolia Electric Power on both trips and have a chance to compete to be a delegate for the National Youth Leadership Council and win a $1,000 scholarship.
During the Cooperative Leaders Workshop, students will tour the Mississippi State Capitol, meet with legislators, and visit the legislative galleries where they will see debates on legislation. They will learn about electric cooperatives, hear dynamic speakers, and take part in several group exercises aimed at building cooperation, trust, and leadership skills. Then, Durr, Richardson, Hornesby and Sterling will travel to Washington, D.C. in June to tour the nation’s capital.
A nominee is chosen by their school counselor based on leadership qualities and community service. Also, a nominee’s parents or guardians must be a member of Magnolia Electric Power.
“Each year, we tell our nominees that they should know that they are already winners when they come in the door because they were chosen by their schools as leaders in their communities,” Shell said. “Their dedication and commitment to make the world better is already being noticed.”

December is here, and if you find any toys on sale, be sure to buy an extra one for the Toys for Tots drive.
MEP will again be supporting Toys for Tots this Christmas, and we are asking our members to help us collect toys for the children. Members can drop toys o in a donation box in the lobby at Magnolia Electric Power.
If you want to participate, please leave an unwrapped toy in the donation box from now until Dec. 13, and we will see that it gets to the proper people.
There are no restrictions on the toys.





The Magnolia Electric Power business o ce will be closed Dec. 24 and 25 for Christmas and Jan. 1 for New Year’s Day.
MEP Linemen will be on call. To report a power outage, call 601-684-4011 or use the SmartHub app









by Jennah Denney















As the holiday season approaches and the days grow colder, you may be considering ways to stay cozy while also managing home energy use.
One of the best ways to make your home more energy e cient is by choosing products with the Energy Star® label. But what exactly does that label mean, and how can it benefit you?
Energy Star® is a program by the U.S. Department of Energy (DoE) and the Environmental Protection Agency (EPA) to help consumers identify energy e cient products that save money and reduce environmental impact.

Products that earn the Energy Star® label must meet strict guidelines for energy e ciency, performance, and cost e ectiveness. Here’s how the process works:
The product must be more energy e cient than typical models. This helps you save on energy bills by using less electricity while still providing the same performance.
The product must be tested in EPA-recognized labs, following standardized procedures. These tests ensure the product meets all energy e ciency and performance requirements.

Once tested, the product’s data is reviewed by a third-party certification body to verify it meets the set standards. This ensures that only the best products receive the Energy Star® label. AMORY – P.O. BOX 300 - 50408 GREENBRIAR ROAD – 662-256-2962 •


Even after a product is certified, the EPA conducts “o -the-shelf” testing on random samples of Energy Star® products to ensure they continue to meet the required standards. If a product fails to meet the performance requirements during verification testing, it can be disqualified from the Energy Star® program. The EPA has clear procedures for handling such disqualifications to maintain the integrity of the label.
To browse products that have earned the Energy Star® label, visit https://www.energystar.gov.



Whether you’re upgrading your refrigerator, replacing light bulbs, or purchasing new electronics, the blue Energy Star® label is your assurance that the product has passed all energy e ciency tests. It’s easy to spot and can be found on products ranging from small and major appliances to electronics.
Many large appliances, such as washing machines and clothes dryers, include a yellow Energy Guide label that provides estimated energy use. Comparing these labels can help you determine how much you’ll save with an Energy Star® model compared to a standard model.

While Energy Star® products can cost a little more upfront, their energy savings over time will often cover the di erence. They help reduce your household energy consumption, which could translate to lower utility bills.
As a member of an electric cooperative, choosing energy e cient products benefits not only you but also our entire community. When co-op members use less energy, it lowers overall electricity demand, helping to stabilize rates and reduce costs for everyone.
As you shop for appliances, electronics, or other home equipment this holiday season, look for the Energy Star® label. Whether it’s a new washing machine or energy e cient lighting options, these products are a simple and e ective way to save money and lower energy use.








QHow can I save in the kitchen during the most expensive time of the year?



AThe holiday season brings opportunities to enjoy meals with friends and family, leading to spending more time in the kitchen. Whether hosting a few or a crowd, consider making new energy e ciency traditions this year with these tips to manage your energy use.


by Miranda Boutelle
Let’s start with cooking your meal. Your electric oven is typically the highest-wattage appliance in the kitchen. Yet, people usually don’t turn their ovens on for long periods of time. Assuming an average oven wattage of 3,000 and an average cost of $0.16 per kilowatt-hour, according to the United States Energy Information Administration, it costs $0.48 an hour. Let’s say you use your oven for four hours to make a special meal. That’s less than $2 of electricity. While that may not seem like a big deal now, operating your oven for four hours every day is $700 a year.
Using smaller appliances instead of your oven can help you save. A slow cooker uses between 100 and 450 watts, which is significantly less than an electric oven at 2,000 to 5,000 watts. That means you can use a slow cooker for a longer period and still use less energy.
Opt for your microwave or toaster oven to reheat or cook smaller items. The microwave uses significantly less energy than the oven. A toaster oven uses about half the energy of a conventional oven, according to Energy Star®.
You also want to avoid turning on your oven and leaving the door open to heat your home. This can break your oven and be a safety hazard, especially with gas ovens that can cause carbon monoxide buildup.
When cooking on the stovetop, match the pot or pan size to the burner. Lids help your pots retain heat, which cooks food faster and wastes less heat. Keep your stovetop clean to ensure the appliance heats evenly.
If you’re looking to upgrade your stovetop, consider switching to an induction cooktop. It uses an electromagnetic field below the surface to heat pots and pans directly. This provides more precise heat, faster cook times and higher e ciency. It can also improve the air quality in your home when compared to a gas cooktop.
In my experience, people like to gather in the kitchen during parties. To avoid overheating your guests in a room that has a hot oven, turn your thermostat down a few degrees before guests arrive.
Next, let’s look for refrigerator savings. The gaskets on your refrigerator doors should make a tight seal to keep in cold air. Make sure you clean and maintain them or replace them if necessary. Don’t let frost build up in the freezer, which can decrease e ciency and make your freezer work harder to maintain a balanced temperature.
In my experience, people like to gather in the kitchen during parties. To avoid overheating your guests in a room that has a hot oven, turn your thermostat down a few degrees before guests arrive.
Wait until food cools before putting leftovers in the fridge. Putting hot food in the refrigerator results in more energy used to cool it down. Aim for about 30 minutes of cool time. Perishable food should be refrigerated within two hours after it is cooked, according to the United States Department of Agriculture.
Setting your refrigerator colder than needed wastes energy. The U.S. Department of Energy recommends 37 degrees for the refrigerator and 0 degrees for the freezer. Use an appliance thermometer to monitor the temperature.
When it comes to cleanup, run full loads of dishes in the dishwasher — being careful not to block any moving parts. Use eco mode if your dishwasher has that setting. If you are in the market for new appliances, select Energy Star® models.
Whatever you choose to cook or how you cook it, keep in mind these simple tips to make your kitchen more e cient and save energy this holiday season.
Miranda Boutelle is the chief operating o cer at E ciency Services Group in Oregon, a cooperatively owned energy e ciency company.




Considering an electric vehicle? Use this guide as you consider vehicle options.
Battery Electric Vehicle (BEV):
Fully powered by an electric battery; no gas-powered components.
BEV: 110-300 miles *full battery
Plug-in
Electric Vehicle (PHEV):
Contains an engine, electric motor and large battery; can operate in electric-only mode, engine-only mode or hybrid mode (battery and gas).
PHEV: 15-60 miles on battery power *full battery (PHEVs can run on battery and/or gas power)
Level 1:
• 110-volt service
• 2-5 miles of range per hour of charging
• Typically does not require electrical upgrades
Level 2:
• 240-volt service
• 10-30 miles of range per hour of charging
• Faster than level 1
• May require electrical upgrades
Hybrid Electric Vehicle (HEV):
Low-emission vehicles; electric motor assists gas-powered engine. Fully powered by gasoline (no charging).
• Public charging options near you
• Federal, state and local financial incentives
• Battery warranties
• Potential changes to auto insurance

















December is a time when I like to reflect back on the year’s challenges and accomplishments. On reviewing these messages, I tend to trend down the path of all the challenges we have. Rising costs, power supply, supply chain issues, in a time of divided leadership seem to dominate my thoughts. I often have to remind myself that this is a time of year to reflect on all the things I am thankful about. While costs of all materials have indeed risen, we still had availability of them when needed. Maintaining relationships with providers has helped us procure, and them supply the equipment and materials required to serve this community. Northcentral is thankful for their partnerships.
Electricity capacity has been a large concern on multiple occasions the last several years. While an immediate resolution hasn’t been determined, I’m happy to be on a Tennessee Valley Authority (TVA) working committee to construct the best path forward. Northcentral is thankful for our partnership with TVA.
There is a myriad of things to be thankful for: the employees who keep our cooperative going, their continued commitment to safety,










our community, our families, and our God. These are things I should constantly be thankful for, not just around Christmas.
As the late Bing Crosby sings in the classic film, “White Christmas,” “When I’m worried, and I can’t sleep, I count my blessings instead of sheep.”
Merry Christmas, Happy Hanukkah, Happy Kwanzaa, Stay safe.

by Kevin Doddridge General Manager/CEO



Hurricane Helene’s disastrous impact on the southeastern United States mobilized Mississippi’s electric cooperatives to assist with power restoration in Florida and Georgia. Over 265 linemen representing 19 Mississippi cooperatives provided aid to several electric cooperatives in rebuilding their systems.
On Sept. 27, Northcentral lineman and equipment were first dispatched to Talquin Electric Cooperative, based in Quincy, Florida. At the height of the storm, Talquin lost power to 63% of the 57,000


SEPT. 27 • TALQUIN ELECTRIC COOPERATIVE
L to R: Willie Dean, Jacob Harrill, Hunter Milloway, Michael Mullins, Logan Rollins, Thomas Ferguson, Floyd Sanderson, and Pat Medlin

meters they serve. Upon completion of that work, crews then assisted Clay Electric Cooperative in areas outside of Gainesville. Clay Electric lost power to over 100,000 members, or 53% of their electric system.
Upon their return, a second wave of assistance from Northcentral was deployed on Oct 6 to assist Je erson Energy Cooperative, based in Wrens, Georgia. Helene took out power to every meter served by Je erson. Northcentral crews spent 10 days helping rebuild their system in an e ort that spanned weeks.


OCT. 6 • JEFFERSON ENERGY COOPERATIVE
L to R: Adam Conway, Kennedy Willis, Ben McCrory, Joseph Branson, Caden Stepp, Josh Hayes, Jonathan Patrick, Zach Humphreys, Cody Williams, and Zac Dias
The 74th Annual Meeting of the members of Northcentral Electric Cooperative convened on Oct. 23, 2024, at 2 p.m., in their auditorium at 4600 Northcentral Way in Olive Branch.
Northcentral Board President Pat Woods welcomed those attending and called the meeting to order. Reverend M.J. Pope, pastor of The Flame of Byhalia Church, was called upon to give an invocation.
Three board members were nominated by the members of their respective districts to run for re-election and were uncontested. Their nominations were certified by the Elections and Credentials Committee on Sept. 17, 2024.

30,554 notices were mailed to the membership on Sept. 26, 2024. Additionally, electronic notices were emailed to all members with an address on file. Members could either submit their proxy online or by return delivery of the paper proxy. Pursuant to the Cooperative’s bylaws, it would take 5%, or 1,527 members, personally present or through proxies for the requirements of a
quorum. Rita Hobbs, chairperson of the cooperative’s Election Committee, reported that a quorum had been met.
Northcentral’s General Manager and CEO Kevin Doddridge presented the 2024 Annual Report for the Cooperative. Doddridge then addressed questions from the floor of those attending.
Hobbs then confirmed that the voting had ended, and the meeting was recessed while the Election Committee tallied the ballots.
The meeting reconvened, and the Election Committee announced they were ready to report the count of the ballots for the election of directors.
Hobbs presented the election results as follows: In District 2, Don Dickerson received 2,138 votes; for District 6, Morris Thompson received 2,138 votes; and in District 9, Julie Niblett received 2,138 votes. Therefore, Dickerson, Thompson, and Niblett were all elected for three-year terms.

There was no further business to come before the meeting, and the meeting was adjourned.



Saturday, Dec. 14 (rain date Dec. 16)
Byhalia Christmas Parade
A Small Town Christmas
6 p.m. • Downtown Byhalia see ad bottom right
Monday, Dec. 2
Hernando Christmas Parade
Candyland Christmas
6 p.m. • Downtown Hernando
Saturday, Dec. 7







Olive Branch Christmas Parade
A Red, White, and Blue Christmas. In honor of Pearl Harbor Day
2 p.m.

Sunday, Dec. 8
Cookies with Santa
2 p.m. to 5 p.m.
Gale Community Center, 2601 Elm St.
Saturday, Dec. 7



Beginning at Olive Branch High School see ad directly below
Saturday, Dec. 7
Southaven Christmas Parade
Candy Cane Lane 10 a.m.- Main Street
Santa’s Workshop and Family Festival Immediately following the parade until 1 p.m.
Horn Lake Christmas Parade
6 p.m.



Toys, Trains & Candy Canes



• Beginning at HL Middle School






Southaven City Hall Arts, Crafts, Food Trucks, Photos with Santa All proceeds benefiting The House of Grace

Presents the



















































































Considering an electric vehicle? Use this guide as you consider vehicle options.
Battery Electric Vehicle (BEV):
Fully powered by an electric battery; no gas-powered components.
BEV: 110-300 miles *full battery
Electric Vehicle (PHEV):
Contains an engine, electric motor and large battery; can operate in electric-only mode, engine-only mode or hybrid mode (battery and gas).
PHEV: 15-60 miles on battery power *full battery (PHEVs can run on battery and/or gas power)
Level 1:
• 110-volt service
• 2-5 miles of range per hour of charging
• Typically does not require electrical upgrades
Level 2:
• 240-volt service
• 10-30 miles of range per hour of charging
• Faster than level 1
• May require electrical upgrades



Hybrid Electric Vehicle (HEV):
Low-emission vehicles; electric motor assists gas-powered engine. Fully powered by gasoline (no charging).
• Public charging options near you
• Federal, state and local financial incentives
• Battery warranties
• Potential changes to auto insurance


Northcentral will be closed Dec. 24 and 25 for Christmas and Jan. 1 for New Year’s. & HAPPY

























Pearl River Valley Electric Power Association has completed a comprehensive, independent, rate study and will implement new rates beginning Jan. 1, 2025. This change marks the first rate adjustment since 2016, when a small increase was made to the daily charge.
Through prudent management and fiscal responsibility, PRVEPA has held o on additional rate increases for nearly a decade. However, inflation and ongoing supply chain disruptions since 2020 have led to significant increases in operational costs.
The largest portion of PRVEPA’s budget goes toward purchasing wholesale power from Cooperative Energy, which accounts for roughly 70% of every dollar spent. As the cost of electricity has increased, so have prices for essential construction materials, including poles, transformers, and wire, as shown in the graphic below.
To address these rising costs and continue delivering reliable service, PRVEPA will increase both the energy charge and the daily charge on Jan. 1.




































“We’ve delayed any rate increases for as long as possible, hoping prices would stabilize,” said CEO and General Manager Matthew Ware. “However, to ensure a high level of service and maintain a reliable electric system, our rates must be adjusted.”
The energy charge reflects the cost of electricity itself, while the daily charge covers the other essential costs required to operate the cooperative — such as poles, wiring, transformers, truck maintenance, and safety equipment for linemen.
For an average member using 1,000 kWh per month, the increase will amount to approximately $12.64 per month, or about 42 cents per day. For members using 2,000 kWh, the average monthly increase will be $20.54, or approximately 68 cents per day.
As always, Pearl River Valley Electric remains committed to controlling costs and providing safe, reliable electric service. Thank you for your continued membership and support.














For over 30 years, Pearl River Valley Electric has sent students on a life-changing trip to Washington D.C. through the Electric Cooperatives of Mississippi Youth Leadership Program. On the trip, students from across Mississippi, picked for their outstanding leadership abilities, visit monuments, the U.S. Capitol and the White House. This trip has served as a hallmark for what electric cooperatives can do to inspire our youth and our communities.
The first step in the Youth Leadership Program is PRVEPA’s Cooperative University which is held at the National Guard Armory in Columbia. Cooperative University is a one-day event where each school is represented by up to two students. The day consists of speakers, games, and various demonstrations. This year, speakers included representatives from Cooperative Energy, past leadership program students and local legislators.
“The program has helped so many students realize a dream of traveling to see our nation’s capital,” said Leif Munkel, manager of marketing, communications and member services. “For many students the trip to
Thanks to all the students who participated in our









Washington D.C. is an eye-opening experience and exposes them up to a much larger world.”
This year, 22 students from 12 schools sent students to the Cooperative University on November 6th. Judges interviewed all 22 students and chose two winners. This year’s winners are Maddie Hylender from Purvis High School and Samantha Cardenas from Sumrall High School.
Maddie Hylender, is active in First Priority, student council and Beta Club. She currently serves as President of First Priority and is Junior Class President. She is also Editor-in-Chief of the Purvis High School Yearbook sta . Samantha Cardenas is in show choir, student government and Diamond Girls. She has helped lead and direct choirs at her church. She is also a recipient of the Heart of Sumrall award.
Maddie and Samantha will join thousands of other students from around the country in June to attend the Youth Tour in Washington D.C. There they will have the opportunities to meet their legislators, tour the U.S. Capitol and do lots of other sightseeing.
Mallorie Blocker
Arianna Bourne
Presley Branch
Cadence Brown
Samantha Cardenas
Anzly Conway
Reed Duncan
Destini Gholar
Alana Nagy
Callie Newsome
Margaret Piland
Izzy Pittman
Lupita Ramon





Emma Roseberry
Ellie Sa e
Louis Schramm
Cela Strickland
Callie Sullivan
Porter Williamson

Helping our communities succeed is the goal of all electric cooperatives, and CoBank’s Sharing Success program helps fulfill that goal. In partnership with CoBank, a national cooperative bank that serves utilities in rural America, Pearl River Valley Electric Power Association has distributed grants this year to area volunteer fire departments and a local children’s home.
The Sharing Success program allows CoBank members, like PRVEPA, to apply for grants which provide matching funds to help non-profit organizations.
This year, Pearl River Valley Electric chose two fire departments, the Lumberton Fire department and the Oloh Volunteer Fire department. Both departments plan to use their donations for firefighting equipment.
Another grant went to the Deanash Baptist Children’s Village near Wiggins. The campus serves 10 at-risk children by providing a stable home environment. The organization plans to use the grant for renovations and essential items for the children.
In total, $10,000 was distributed through the program this year. In the past three years, Sharing Success grants have provided $30,000 towards assisting non-profits in our service territory. Pearl River Valley Electric hopes to continue participating in CoBank’s Sharing Success program in the years to come.
























From our co-op family to yours, wishing you a blessed Christmas season and a joyous new year.

All Pearl River Valley Electric o ces will be closed Dec. 24 and 25 for Christmas and Jan. 1 for New Year’s Day. Dispatchers will be on duty.









Pearl River Valley Electric Power Association linemen helped restore power in Florida after back-to-back hurricanes hit the state. In late September, in the wake of Hurricane Helene, crews went to Talquin Electric Cooperative to help their members. After restoring power there, they moved on to TriCounty Electric. A week later, Hurricane Milton struck Florida, and more crews left to help assist Peace River Electric Cooperative near Tampa, Florida. Thank you to all the crews who went to assist cooperative members in Florida. It’s your dedication that helps us exemplify the cooperative principle of “cooperation between cooperatives.” Here are a few pictures taken by crew foremen, Pat Linton and Tommy Baughman.






























PEPA has sent members of our crews to Community Helper Days and other events in our service area. Recently, we’ve been part of the K4 and K5 Community Helper Day at Bruce Elementary, the Calhoun County Elementary Career Fair for third and fourth grade students, and First Responder Day at Pontotoc’s Head Start location. PEPA is proud to partner with these local groups to teach electric safety and spotlight careers in the electric utility industry.








O ces will be closed Dec. 24 and 25 for Christmas and Jan. 1 for New Year’s Day.
To report outages or emergencies, please call 662-489-6711 for Pontotoc or 662-983-2727 for Bruce.

A Pontotoc Electric dispatcher is on duty 24-hours a day, seven days a week.



by Jennifer Johnson
The turkey and dressing has been eaten, and we’ve counted our blessings (as we should!). Christmas will be here before we know it.
For many families, the Christmas season is celebrated in the days and weeks leading up to Dec. 25, and employees in our PEPA o ce are no di erent. Here are some of our traditions which may be similar to those your family enjoys, or who knows maybe this will be the year you incorporate one of ours! Merry Christmas from all of us to all of you!



“Every year, my dad, my siblings, and our families have a get together on Christmas Eve at my dad’s house. We have a devotion with a song and prayer. Everyone brings a dish and my brother always volunteers to make his famous seafood gumbo! After we eat, we play dirty Santa or we will let everyone open a gift. It’s always enjoyable.”

“We always like to go looking at the Christmas lights around the area, and every Christmas Eve, the menu is shrimp and grits.”



“We read the Christmas story from Luke 2, and we read 'Twas the Night Before Christmas.' During 'Twas the Night Before Christmas,' we play a game. Everyone gets in a big circle, and one person will start out holding a single gift. Every time you hear a certain word (usually ‘the’), the gift gets passed to the right. The person with the gift at the end of the book gets the gift.”


“For the past few years, my husband, our adult children, and I have had a Christmas game night. I’ll look up the “Minute to Win It” type games and gather what we need ahead of time. We eat supper together, play games, and then enjoy homemade hot chocolate in my Christmas mugs that have been collected over the years. We give away small gift cards (like fast food) and some small prizes. It’s a big hit in our family!”


“We always watch ‘National Lampoon’s Christmas Vacation’ on Christmas Eve.”


“My immediate family (Eddie, Charlie, Molly, and I) have a full Christmas breakfast for just the four of us on Christmas morning. This is a special time – especially now that Charlie and Molly are adults and we do not see them very often. We will have our gift exchange (again just the four of us). We have always enjoyed having our special time together before joining extended family for all the normal hustle and bustle of the Christmas season.”

“For several years, I have bought Christmas pajamas for my mom, my husband Terry, and myself. We wear them on Christmas Eve.”
We have the side dishes covered for your Christmas feasts!
Karen Laprade, PEPA Plant Accounting Clerk
INGREDIENTS
1 can crescent rolls
2 cups water, divided
2 cups sugar
2 sticks butter

8 sweet potato patties
2 tablespoons all-purpose flour
1 teaspoon vanilla cinnamon to taste
Cut rolls into 16 strips. Cut sweet potato patties in half. Roll crescent rolls around the potatoes and place in a greased 9" x 13" dish. Combine one-half of the water and flour and bring to boil. Add rest of water, sugar, and butter until slightly thick. Add vanilla and pour over crescent rolls. Sprinkle with cinnamon. Bake at 350 degrees until brown. Makes 16.
Sue Cook, PEPA Retiree
INGREDIENTS
1 pound Velveeta cheese
1 stick butter
1 tablespoon flour
1 cup milk
12 ounces elbow macaroni
Cook noodles until tender. Melt butter in microwave, add flour, stir until smooth. Add milk. Chop up cheese and add to milk. Melt in microwave until sauce is completely melted. Stir until smooth. Pour over noodles.
Mary Williamson, PEPA Collections Manager
INGREDIENTS
¼ cup salad oil
½ cup sugar
1 tablespoon Worcestershire sauce
2 cups sliced, cooked carrots
1 green pepper, sliced
Salt and pepper to taste
2⁄3 cup cider vinegar
1 teaspoon dry mustard
1 cup tomato soup
1 onion, sliced
1 garlic clove, minced
Blend oil, vinegar, sugar, mustard, Worcestershire, and soup. Bring to a boil. Remove from heat. Add carrots, onion, peppers, and garlic. Salt and pepper to taste. Marinate overnight.
Jennifer Johnson, PEPA HR Manager
INGREDIENTS
1 head Romaine lettuce, torn into pieces
4 green onions, chopped
1 package Ramen noodles, discard seasoning
1 cup sugar
3 teaspoons soy sauce
1 bunch broccoli, chopped
1 cup chopped walnuts
1 cup vegetable oil
½ cup red wine vinegar
Salt and pepper to taste
Place lettuce, green onions, and walnuts in bowl. To make dressing: Combine red wine vinegar, vegetable oil, sugar, soy sauce, salt, and pepper. Place Ramen noodles in zip top bag and break them up. Saute’ Ramen noodles in 4 tbsp butter until lightly browned. Allow to cool on paper towel. Pour dressing over salad and add Ramen noodles just before serving.

Pontotoc Electric Power Association mourns the passing of former PEPA Board Member Nickey Browning, who passed away on Oct. 29, 2024.













The holiday season brings a spirit of generosity and compassion and is the time to reflect on our many blessings and uplift those in need. While this is certainly a special time of year, cooperatives like Singing River Electric are deeply rooted in giving back to their local communities year-round.
Our mission is reliable power. Our purpose is people—the members we are proud to serve. That’s why we volunteer our time for local projects, help non-profit organizations through the Neighbors Helping Neighbors Community Grant Program, and participate in youth safety education at local schools – all to make a positive, meaningful impact on our community.
You help us power that purpose too. Our Neighbors Helping Neighbors Energy Assistance (NHNEA) program is made possible through members’ participation in ‘rounding up’ electric bills to the next whole dollar amount. Annual donations average just $6 per household. Your generous contributions help less fortunate families in our community with their power bills when they need it most.
Another way Singing River Electric gives back is by investing in tomorrow’s leaders. Through presentations at local schools, scholarship














BRIAN


opportunities through our local chambers of commerce, and the Cooperative Youth Leaders program, we aspire to empower students for a brighter future. When we invest in our local youth, we strengthen the fabric of our community.
As a not-for-profit electric cooperative, we believe in giving credit where credit is due—to the members who shape our co-op. One of the ways we do this is through capital credits. Because Singing River Electric operates at cost, we give back any remaining revenue to our members rather than outside shareholders or investors. As stated in last month’s column, more than $5 million in capital credits was retired to Singing River Electric members this year. Giving back to our local members instead of outside parties is one of the many aspects that set cooperatives apart from other businesses.
Our members guide every decision we make and are the reason our cooperative exists. To us, you’re more than a customer – you are a member. This holiday season, we hope you’re proud to be a part of a community-focused cooperative that puts people before profits.
From your friends and neighbors at Singing River Electric, we wish you a blessed Christmas and a Happy New Year.







































When decorating your home this holiday season, consider using LED light strings. Energy Star certified light strings use 75% less energy than traditional incandescent light strings. These LEDs also last up to 100,000 hours vs. 3,000 hours for incandescents. They are available in a variety of colors, shapes, and lengths.

Installing an outdoor timer on your decorations can help manage your Christmas lights when unexpected delays happen in your day-to-day life. If you forget to turn the lights o or have an overnight stay, your outdoor timer will control the decorations for you – less worry and more enjoyment during the holidays. The outdoor timer will work for inflatable decorations as well. Running an inflatable can cost around $16-25 a month if it runs 24 hours a day. With the outdoor timer, you can eliminate unwanted run time without manually doing so and reduce your energy consumption.






















































Singing River Electric hosted its youth leadership Cooperative University on Oct. 31.



















Fourteen high school juniors nominated by their schools learned about the cooperative form of business, how SRE provides power and restores outages, and Singing River Connect fiber internet.
A legislative panel discussion driven by student questions was a highlight of the day. Thank you to Secretary of State Michael Watson, Senator Chris Johnson, Representative Elliot Burch, and Representative Steve Lott for serving on the panel.
Each student also participated in a 10-minute interview. Based on participation and interview rankings decided by out-of-town judges from electric cooperatives across the state, three students were selected to attend the 2025 Cooperative Leaders Workshop in Jackson, Miss. and 2025 Youth Tour of Washington, D.C.











These three students will attend the 2025 Cooperative Youth Leaders Workshop in Jackson and Youth Tour of Washington,

























These students were their high school’s representatives based on their leadership skills and community activities.






A highlight for Singing River Connect representatives is visiting with subscribers and Singing River Electric members in our local communities, like we did at Vancleave High School football, East Central High School football and homecoming games, and George Regional Health System Foundation’s annual golf tournament.
Singing River Connect is proud to be your trusted local provider of lightning-fast fiber internet. Get Connected. Stay Local.































Forts Lake, Helena, Helena Industrial, Escatawpa South, Wade, Cumbest Bluff, Benndale, Rocky Creek, Leakesville, Lucedale North, Vancleave, Joe Batt, and all previously opened areas Planning the most efficient approach to fiber deployment. Building a network from the ground up.

Lake, Helena, Helena Industrial, Escatawpa South, Wade, Cumbest Bluff, Benndale, Rocky Creek, Leakesville, Lucedale North, Vancleave, Joe Batt, and all previously opened areas










For the second time this hurricane season, Singing River Electric linemen traveled to Florida to help fellow electric cooperatives in need.
On October 10, the 11-man crew first went to Clay Electric Cooperative, based in Keystone Heights, Fla., where 34,911 of their 195,523 meters were without power after Hurricane Milton. Their service area is vast, covering 15 counties and including areas around Gainesville, Jacksonville, and Daytona Beach.
“We’re going to get some lights on,” said Construction Foreman Chris Lloyd, who was also a crew member who helped Clay Electric in 2017 after Hurricane Irma.
After finishing power restoration at Clay Electric, the linemen drove south to Glades Electric Cooperative based in Moore Haven, Fla. Glades Electric had 11,686 of their 18,000 meters without power the morning after the storm passed and 75 broken poles caused by tornadoes.


Singing River Electric employees joined Mississippi Power and Singing River Federal Credit Union for the Renew Our Rivers event, removing more than six tons of debris and trash from the lower Pascagoula River on Oct. 18.





















Round up your electric bill to the nearest whole dollar and help a neighbor in need. Donations average only $6 per year and collectively help pay power bills for fellow Singing River Electric members needing a helping hand.





To round up, click the “Give Joy” button on the SmartHub app, visit singingriver.com/give-joy, or text a member service representative at 228-591-9166.















As 2024 ends, I want to take a moment to provide an update on Southern Pine’s commitment to reliability. This year has been marked by continued improvements to our infrastructure and maintenance activities to provide the reliable service our members expect and deserve.
With over 10,700 miles of distribution lines through some very rough and tree-lined terrain, the most essential maintenance task is right-of-way (ROW) trimming and spraying. Our ROW maintenance is on a four-year cycle. This cycle requires we trim and spray over 2,000 miles of right-of-way each year. We added full floor bushhogging to the plan in our current four-year cycle. This addition has resulted in crews performing quicker corrective work when outages occur, as they can more easily move along the right-of-way. I am pleased to report that the 2024 right-of-way trimming and spraying plan was completed on schedule.
Additionally, the drought that occurred in 2023 resulted in an extreme number of dead trees throughout Mississippi, including much of Southern Pine’s territory. This issue has resulted in an increased number of non-weather-related outages. To combat this challenge, Southern Pine deployed contract crews throughout the system that are doing nothing but downing dead trees. This work began in October, and as I write this article, over 25,000 dead trees have been removed. This work will continue throughout 2025.



from Southern Pine Electric

Beyond these e orts, we also conducted scheduled infrared inspections of substations and performed pole inspections, including replacing any identified bad poles and several other planned maintenance activities. Additionally, we started a reclosure and regular maintenance program, which will continue into the future.
While much time and attention goes into maintaining your distribution system, we are still unsatisfied. In fact, Southern Pine’s board of directors conducted a strategic planning session in 2024. One of the resulting strategic priorities was to “achieve operational excellence by improving the reliability and resiliency of the distribution system through a robust maintenance and system planning program.” Our team, responsible for this strategic priority, has been hard at work evaluating our current maintenance practices and investigating new practices that can move us forward toward operational excellence to benefit you, our members.
I hope you all have a Merry Christmas, and we look forward to serving you even better in 2025.

by Chris K. Rhodes
President/CEO Southern Pine Electric


This holiday season, all of us at Southern Pine Electric want to wish you and your family a Merry Christmas and a bright New Year. We’re grateful to be a part of your everyday lives, powering your homes, lighting up your celebrations, and making cherished moments just a little warmer and brighter.
As your neighbors, friends, and family, we’re honored to serve you. From every Southern Pine employee, thank you for being part of our cooperative family. May your holidays be filled with peace, joy, and the comfort of home.
Warm holiday wishes, The Southern Pine Electric Family






In rural Taylorsville, Mikayla and Kaden James live a life grounded in love, service, and cooperation. Mikayla works as a purchasing specialist at Southern Pine Electric, while Kaden is a lineman at Dixie Electric. Together with their baby son, KJ, they embody the cooperative spirit, bringing the values of service and teamwork into their home and community.
Mikayla began her career in Southern Pine’s call center, where her warmth and dedication quickly made her a favorite among members. Known for her caring approach, she earned a new role in supply chain, making sure field crews have the materials they need to keep the lights on. “It’s about supporting the team,” Mikayla says. “I love knowing I play a part in keeping things running.”
At home, her teammate is Kaden, who works long days restoring power as a lineman. It’s challenging, especially during storms, but Kaden takes pride in his role. “When the lights go out, we’re the ones people rely on,” he explains. “That’s a responsibility I hold close.”
Though they work for di erent cooperatives, Mikayla and Kaden share a common goal: serving their communities. They’re also raising KJ with those same values, instilling a love for community and service in him from an early age. Mikayla jokes that he’s already “a little Southern Pine and Dixie Electric man.”
Living in Taylorsville means more than just a quiet life—it’s about supporting neighbors and friends. “We know the people we’re serving,” Mikayla says. “It’s about making sure our community is taken care of.” Kaden agrees, adding, “In a small town, everyone depends on each other. Working for a co-op means we’re all in it together.”
While KJ brings joy to their lives, Mikayla and Kaden remain committed to their work at Southern Pine and Dixie Electric, building a legacy of service and cooperation. In a world often divided, they show that cooperation—both at work and at home— makes a di erence. The James family is proof that the power of love and community shines as brightly as the lights they help provide.















Nestled in the charming town of Mount Olive, Marilyn Diehl’s Basket Cottage is a testament to a family tradition turned thriving business. It all began with her nephew, Roger Jamison, who took up basket weaving at just 13 years old. By 18, he was accepted into the prestigious Craftsmen’s Guild of Mississippi, Inc., a recognition of his talent and dedication. Watching Roger’s passion grow, Marilyn, a teacher herself, became captivated by the craft. She spent several years helping him, never imagining that in 2002, she’d buy the business, moving his 500-square-foot shop to the family home o Highway 532 near Hot Co ee.
In 2015, Marilyn moved her shop to Main Street in Mount Olive, rebranding it as the Basket Cottage. Marilyn’s baskets have since gained acclaim, shipped across the U.S., Canada, Italy, Germany, Brazil, and England, admired for their craftsmanship and unique character.

She weaves her baskets from split rattan, using solid hickory and oak for handles, and trims them with seagrasses, round reed, and cane.
At the heart of each piece is Marilyn’s commitment to quality materials and traditional methods. She weaves her baskets from split rattan, using solid hickory and oak for handles, and trims them with seagrasses, round reed, and cane. To add a touch of local flair, Marilyn dyes her baskets using natural pigments from pecan and black walnut shells. After boiling the shells for hours, she strains out the solids, creating a rich dye into which she dips each basket, resulting in a warm, earthy tone that celebrates the Mississippi landscape.
Every Basket Cottage creation is a blend of artistry and legacy — dated, numbered, and signed by Marilyn herself. These baskets make thoughtful gifts and can be used throughout the home, each piece a reminder of the enduring beauty of handmade craft. Marilyn’s Basket Cottage has not only carried on a family tradition but has become a community treasure, bringing art, nature, and local heritage together in each unique, handcrafted piece.



































Aby Miranda Boutelle
Let’s start with cooking your meal. Your electric oven is typically the highest-wattage appliance in the kitchen. Yet, people usually don’t turn their ovens on for long periods of time. Assuming an average oven wattage of 3,000 and an average cost of $0.16 per kilowatt-hour, according to the United States Energy Information Administration, it costs $0.48 an hour. Let’s say you use your oven for four hours to make a special meal. That’s less than $2 of electricity. While that may not seem like a big deal now, operating your oven for four hours every day is $700 a year.
Using smaller appliances instead of your oven can help you save. A slow cooker uses between 100 and 450 watts, which is significantly less than an electric oven at 2,000 to 5,000 watts. That means you can use a slow cooker for a longer period and still use less energy.
Opt for your microwave or toaster oven to reheat or cook smaller items. The microwave uses significantly less energy than the oven. A toaster oven uses about half the energy of a conventional oven, according to Energy Star®.
You also want to avoid turning on your oven and leaving the door open to heat your home. This can break your oven and be a safety hazard, especially with gas ovens that can cause carbon monoxide buildup.
When cooking on the stovetop, match the pot or pan size to the burner. Lids help your pots retain heat, which cooks food faster and wastes less heat. Keep your stovetop clean to ensure the appliance heats evenly.
If you’re looking to upgrade your stovetop, consider switching to an induction cooktop. It uses an electromagnetic field below the surface to heat pots and pans directly. This provides more precise heat, faster cook times and higher e ciency. It can also improve the air quality in your home when compared to a gas cooktop.
In my experience, people like to gather in the kitchen during parties. To avoid overheating your guests in a room that has a hot oven, turn your thermostat down a few degrees before guests arrive.
Next, let’s look for refrigerator savings. The gaskets on your refrigerator doors should make a tight seal to keep in cold air. Make sure you clean and maintain them or replace them if necessary. Don’t let frost
The holiday season brings opportunities to enjoy meals with friends and family, leading to spending more time in the kitchen. Whether hosting a few or a crowd, consider making new energy e ciency traditions this year with these tips to manage your energy use.
build up in the freezer, which can decrease e ciency and make your freezer work harder to maintain a balanced temperature.
Wait until food cools before putting leftovers in the fridge. Putting hot food in the refrigerator results in more energy used to cool it down. Aim for about 30 minutes of cool time. Perishable food should be refrigerated within two hours after it is cooked, according to the United States Department of Agriculture.

When shopping for new kitchen appliances, look for the Energy Star® logo. Energy Star® certification indicates the appliance is optimized for e ciency and energy savings, while also providing improved performance, quality, and durability.
Setting your refrigerator colder than needed wastes energy. The U.S. Department of Energy recommends 37 degrees for the refrigerator and 0 degrees for the freezer. Use an appliance thermometer to monitor the temperature.
When it comes to cleanup, run full loads of dishes in the dishwasher — being careful not to block any moving parts. Use eco mode if your dishwasher has that setting. If you are in the market for new appliances, select Energy Star® models.
Whatever you choose to cook or how you cook it, keep in mind these simple tips to make your kitchen more e cient and save energy this holiday season.
Miranda Boutelle is the chief operating o cer at E ciency Services Group in Oregon, a cooperatively owned energy e ciency company.










































Southwest Electric held its 8th annual Cooperative University on Thursday, Nov. 7, at the Natchez Campus of Copiah-Lincoln Community College. Seventeen students from nine schools competed to become the 2025 representatives for Southwest Electric. The students had a full day of learning about the cooperative business model, electricity and the history of rural electric cooperatives, as well as hearing from elected o cials. They had hands-on experience holding tools the linemen use, learning how a meter works, tying wire to a cross-arm and seeing the inside of a transformer. Out-of-town judges chose a smaller group of students to return Friday, Nov. 8, for interviews. Southwest Electric has participated in the Cooperative Youth Leaders program administered by the Electric Cooperatives of Mississippi for over 30 years.
Aliya Haney • Wilkinson County Christian Academy
Ari McDonald • Natchez Early College Academy
Cooper Creel • Loyd Star Attendance Center

DaKia Cameron • Je erson County High School
Donovan Wilson • Franklin County High School
Elle Gage • Brookhaven Academy
Emma King • Loyd Star Attendance Center
Faith Anne Johnson • Cathedral High School


Kate Whitman • Cathedral High School
Keldrick Wilson • Je erson County High School
Kenzie Collins • Natchez High School
Kilya Singleton • Natchez Early College Academy
Kynnedi Smith • Brookhaven High School
Kyra Singleton • Natchez High School
Miley Mayfield • Brookhaven High School
Payshunce Hall • Brookhaven Academy
Tyranny Timmons • Franklin County High School



































Have you tried our FREE Residential Energy Advisor tool? Simply answer 10 questions and provide details about, for instance, the size of your house and the type of insulation. The tool will provide you with an annual electric cost breakdown showing how much of your energy dollars are spent on heating, cooling, cooking and more. It’s free and only takes a few minutes to complete.
Available to Southwest Electric Members:
Residential Energy Advisor
Conduct a Virtual Energy Assessment of your home. It takes just a few minutes to profile your home and get savings recommendations.
Energy Basics
Would you like to learn some basics about electricity and energy use? Use our resources to learn more about electricity.
Appliance Calculator
Try comparing the operating cost of a microwave or small countertop cooker to a conventional oven. You might just be surprised.

TV Calculator
How many televisions do you have? Many homes have more than one. Compare operating costs of di erent sizes and types of televisions.
Lighting Calculator
What would happen if you replaced all of your incandescent light bulbs in your house with LEDs? You might be surprised at how much money you could save monthly.

Ensure a merry and bright holiday season by safely maintaining your tree with the following tips.
Carefully inspect all electric decorations before you use them. Cracked or damaged sockets and/or loose or exposed wires can cause serious shock or start a fire.
Check the water level daily to ensure your tree stays hydrated. Some trees require up to a gallon of water each day.
Trim the tree’s stump by at least two inches on freshly cut trees. Allow it to absorb water for 24 hours before bringing it inside.






Examine extension cords and lights for signs of damage. Frayed electric cords should be discarded.


Make sure your tree is at least three feet away from any heat source like an airduct, fireplace or space heater.



We want to wish all our


a Merry Christmas! Our o ce will be closed Tuesday and Wednesday, Dec. 24 and 25, for Christmas and Wednesday, Jan. 1, for New Year’s Day.
Dispatchers will remain on duty and crews will be on call throughout the holiday weekends. To report an outage, use the SmartHub app, text OUT to 844-975-2728 or call 800-287-8564.


















by Steven Ward











Alice Jones’ father and brothers were all in the U.S. Army.
When she was young, she remembers her father and his military veteran friends hanging out at the house talking and swapping stories while sitting around a table.
“I think that’s where I got that passion for veterans from. I just think there’s so much love, friendship, and camaraderie between veterans. My father had that. They truly loved each other,” Jones said.
Jones is one of the forces behind the annual Veterans Day presentation at Zion Hill No. 1 Baptist Church in Natchez.
The event — an ongoing tradition for 14 years — was held on Nov. 10 during the church’s 8 a.m. service.
The idea came from the church’s pastor, The Rev. Joe W. Pickett.
Jones said Pickett went to four members of the church congregation — Jones, Linda Williams, Carol Merritt, and Rosena Profice — to put the celebration together.
Although Williams and Merritt have passed, Jones and Profice are the movers and shakers behind the event today.
“We do this each year to honor our veterans and give thanks. They have given the ultimate sacrifice, so we want to pay homage to them,” Jones said.
Jones said just over 140 veterans from Mississippi and Louisiana were invited to the 2024 event.
Each veteran who attended received a gift bag and the chance to win door prizes. A new television was the grand prize. Jones said the widows of deceased veterans were also invited and received gift bags.




Jones said Profice is the person who works so hard every year to secure the gift bags and seeks help from the community for door prizes.
“I would say our recognition has become an outreach ministry because it brings the community and surrounding area together with one common goal in mind — saying thank you to veterans in a tangible manner. We are all about the business of honoring and recognizing veterans for making the ultimate sacrifice,” Profice said.
The service included patriotic songs and a special message from Pickett.
Following the service, the veterans were treated to a brunch.
This year’s event was the first to be held inside the church since the COVID pandemic.
Jones called the veterans who attend the church’s event “the most grateful group of people” she has ever come across.
“They always tell us that the fact we acknowledge them at all means so much to them. Gifts are just extra,” Jones said.
“For me, I love that we can show them that their sacrifice is an ever-present thing.”
Profice agreed with Jones.
“I feel that it is my patriotic duty to assist those who gave their service to this country and state. I can only imagine what they endured to reach veteran status,” Profice said.






















by Jennah Denney




As the holiday season approaches and the days grow colder, you may be considering ways to stay cozy while also managing home energy use.
One of the best ways to make your home more energy e cient is by choosing products with the Energy Star® label. But what exactly does that label mean, and how can it benefit you?
Energy Star® is a program by the U.S. Department of Energy (DoE) and the Environmental Protection Agency (EPA) to help consumers identify energy e cient products that save money and reduce environmental impact.

Products that earn the Energy Star® label must meet strict guidelines for energy e ciency, performance, and cost e ectiveness. Here’s how the process works:
The product must be more energy e cient than typical models. This helps you save on energy bills by using less electricity while still providing the same performance.
The product must be tested in EPA-recognized labs, following standardized procedures. These tests ensure the product meets all energy e ciency and performance requirements.

Once tested, the product’s data is reviewed by a third-party certification body to verify it meets the set standards. This ensures that only the best products receive the Energy Star® label.


Even after a product is certified, the EPA conducts “o -the-shelf” testing on random samples of Energy Star® products to ensure they continue to meet the required standards. If a product fails to meet the performance requirements during verification testing, it can be disqualified from the Energy Star® program. The EPA has clear procedures for handling such disqualifications to maintain the integrity of the label.
To browse products that have earned the Energy Star® label, visit https://www.energystar.gov.










Whether you’re upgrading your refrigerator, replacing light bulbs, or purchasing new electronics, the blue Energy Star® label is your assurance that the product has passed all energy e ciency tests. It’s easy to spot and can be found on products ranging from small and major appliances to electronics.
Many large appliances, such as washing machines and clothes dryers, include a yellow Energy Guide label that provides estimated energy use. Comparing these labels can help you determine how much you’ll save with an Energy Star® model compared to a standard model.

While Energy Star® products can cost a little more upfront, their energy savings over time will often cover the di erence. They help reduce your household energy consumption, which could translate to lower utility bills.
As a member of an electric cooperative, choosing energy e cient products benefits not only you but also our entire community. When co-op members use less energy, it lowers overall electricity demand, helping to stabilize rates and reduce costs for everyone.
As you shop for appliances, electronics, or other home equipment this holiday season, look for the Energy Star® label. Whether it’s a new washing machine or energy e cient lighting options, these products are a simple and e ective way to save money and lower energy use.













































































I NGREDIENTS
½ cup butter, melted



½ cup flour









1 cup sugar
2 eggs







1 teaspoon vanilla
½ teaspoon salt



1 cup chopped pecans
1 cup chocolate chips
















1 frozen pie crust





Mix butter and sugar. Add eggs and vanilla and mix well. Add salt and flour and mix well. Fold in pecans and chocolate chips. Pour mixture into pie crust and bake at 325 degrees for 1 hour. Let cool for 1-2 hours before slicing.
I NGREDIENTS
7-8 cups bread cubed into 1-inch
3 ½ cups heavy cream divided
1 cup milk
½ cup sugar
2 tablespoons vanilla extract
18 ounces white chocolate chips
7 egg yolks
2 eggs
Preheat oven to 350 degrees. Spray a 9×13 baking dish with cooking spray.
In large saucepan over medium heat combine 3 cups whipping cream, milk and sugar. Bring to simmer, stirring until sugar dissolves. Remove from heat and whisk in 12 ounces of chocolate until melted and smooth. Let sit to cool slightly, about 10 minutes.
In a large bowl combine yolks and eggs to blend. Slowly whisk in warm chocolate mixture to combine. Whisk in vanilla. Gently fold in the bread cubes and let soak for 30 minutes. Pour into the prepared pan, and cover with foil.
Bake 30 minutes, then uncover and bake until top is golden brown, about 10-15 minutes. While the bread pudding is baking, make the white chocolate sauce.
Use a microwave-safe bowl to heat the white chocolate with the heavy-cream for a minute. Stir until chocolate has completely melted. Pour over each bread pudding serving.







Chyron Wallace Accounting Specialist
Tippah EPA


Lily Wegmann Customer Service Tippah EPA



Tippah Electric Power Association will be closed Dec. 24 and Dec. 25 for Christmas, and Dec. 31 and Jan. 1 for New Year’s.
Call 662-837-8139 or use the TEPA Mobile app to report a power outage or emergency. Servicemen are on call. & HAPPY NEW YEAR






Recently, a crew of Tippah EPA linemen traveled to Douglas, Georgia to assist Satilla REMC in repairing damage from Hurricane Helene. The linemen worked long hours for several days to help restore power to those a ected by the storm.



Tippah Electric Power Association will hold its annual meeting on Thursday, Dec. 12, 2024, 5:30 p.m. at the Tippah Electric o ce at 109 E. Cooper St., Ripley, MS 38663.

You may qualify for federal assistance, making your phone and internet more a ordable.
Lifeline is a federal program dedicated to making phone and internet service more a ordable for low-income households. This benefit provides eligible consumers with a monthly discount of up to $9.25. Check online at https://www.lifelinesupport.org/get-started to see if you qualify.
If you have any questions about these programs, please call the TEPAConnect office at 662-587-9055.



























Twin County Members:
from

twincoepa.com




@twincoepa
Hollandale - 662-827-2262 | Belzoni - 662-247-1909 | Greenville - 662-334-9543 | Rolling Fork - 662-873-4233 | REPORT OUTAGES 866-897-7250 SERVING MORE THAN 12,600 ELECTRIC METERS IN SEVEN DELTA COUNTIES

As the holiday season approaches, we would like to take this opportunity to extend our sincerest gratitude for your unwavering support throughout the year. Your loyalty is the foundation of our success, and we are incredibly thankful to have you as a member of Twin County Electric Power Association.
A fundamental principle of our electric cooperative is “Concern for Community.” Our Twin County employees exemplify this commitment daily, consistently seeking ways to go above and beyond for the communities we serve. I take immense pride in leading this remarkable group of individuals who demonstrate genuine care and dedication to our members, the communities we serve, and our cooperative mission. It is one of the greatest blessings of my role. Together, we embrace the spirit of the community, and I am deeply thankful to everyone who participates in this rewarding journey of service to others.
As you navigate through the hustle and bustle of the holiday season, I encourage you to extend kindness, support, and service to your family, friends, neighbors, and coworkers. Many individuals may find themselves facing this holiday season without the comfort and support of others. By sharing your blessings with them and o ering your time, concern, and appreciation, you can make a significant di erence in their lives. Your generosity can uplift spirits and elevate the holiday spirit of others.
Thank you, Twin County members, for being an invaluable part of our organization. We eagerly anticipate continuing to serve you and your communities in the upcoming year. May you experience the joy, warmth, and cherished moments with those you hold dear this holiday season.
Warm regards,
Leslie Holloway

by Leslie Holloway
General Manager








QHow can I save in the kitchen during the most expensive time of the year?



AThe holiday season brings opportunities to enjoy meals with friends and family, leading to spending more time in the kitchen. Whether hosting a few or a crowd, consider making new energy e ciency traditions this year with these tips to manage your energy use.


by Miranda Boutelle
Let’s start with cooking your meal. Your electric oven is typically the highest-wattage appliance in the kitchen. Yet, people usually don’t turn their ovens on for long periods of time. Assuming an average oven wattage of 3,000 and an average cost of $0.16 per kilowatt-hour, according to the United States Energy Information Administration, it costs $0.48 an hour. Let’s say you use your oven for four hours to make a special meal. That’s less than $2 of electricity. While that may not seem like a big deal now, operating your oven for four hours every day is $700 a year.
Using smaller appliances instead of your oven can help you save. A slow cooker uses between 100 and 450 watts, which is significantly less than an electric oven at 2,000 to 5,000 watts. That means you can use a slow cooker for a longer period and still use less energy.
Opt for your microwave or toaster oven to reheat or cook smaller items. The microwave uses significantly less energy than the oven. A toaster oven uses about half the energy of a conventional oven, according to Energy Star®.
You also want to avoid turning on your oven and leaving the door open to heat your home. This can break your oven and be a safety hazard, especially with gas ovens that can cause carbon monoxide buildup.
When cooking on the stovetop, match the pot or pan size to the burner. Lids help your pots retain heat, which cooks food faster and wastes less heat. Keep your stovetop clean to ensure the appliance heats evenly.
If you’re looking to upgrade your stovetop, consider switching to an induction cooktop. It uses an electromagnetic field below the surface to heat pots and pans directly. This provides more precise heat, faster cook times and higher e ciency. It can also improve the air quality in your home when compared to a gas cooktop.
In my experience, people like to gather in the kitchen during parties. To avoid overheating your guests in a room that has a hot oven, turn your thermostat down a few degrees before guests arrive.
Next, let’s look for refrigerator savings. The gaskets on your refrigerator doors should make a tight seal to keep in cold air. Make sure you clean and maintain them or replace them if necessary. Don’t let frost build up in the freezer, which can decrease e ciency and make your freezer work harder to maintain a balanced temperature.
In my experience, people like to gather in the kitchen during parties. To avoid overheating your guests in a room that has a hot oven, turn your thermostat down a few degrees before guests arrive.
Wait until food cools before putting leftovers in the fridge. Putting hot food in the refrigerator results in more energy used to cool it down. Aim for about 30 minutes of cool time. Perishable food should be refrigerated within two hours after it is cooked, according to the United States Department of Agriculture.
Setting your refrigerator colder than needed wastes energy. The U.S. Department of Energy recommends 37 degrees for the refrigerator and 0 degrees for the freezer. Use an appliance thermometer to monitor the temperature.
When it comes to cleanup, run full loads of dishes in the dishwasher — being careful not to block any moving parts. Use eco mode if your dishwasher has that setting. If you are in the market for new appliances, select Energy Star® models.
Whatever you choose to cook or how you cook it, keep in mind these simple tips to make your kitchen more e cient and save energy this holiday season.
Miranda Boutelle is the chief operating o cer at E ciency Services Group in Oregon, a cooperatively owned energy e ciency company.






by Jennah Denney



As the holiday season approaches and the days grow colder, you may be considering ways to stay cozy while also managing home energy use.
One of the best ways to make your home more energy e cient is by choosing products with the Energy Star® label. But what exactly does that label mean, and how can it benefit you?
Energy Star® is a program by the U.S. Department of Energy (DoE) and the Environmental Protection Agency (EPA) to help consumers identify energy e cient products that save money and reduce environmental impact.

Products that earn the Energy Star® label must meet strict guidelines for energy e ciency, performance, and cost e ectiveness. Here’s how the process works:
The product must be more energy e cient than typical models. This helps you save on energy bills by using less electricity while still providing the same performance.
The product must be tested in EPA-recognized labs, following standardized procedures. These tests ensure the product meets all energy e ciency and performance requirements.

Once tested, the product’s data is reviewed by a third-party certification body to verify it meets the set standards. This ensures that only the best products receive the Energy Star® label.


Even after a product is certified, the EPA conducts “o -the-shelf” testing on random samples of Energy Star® products to ensure they continue to meet the required standards. If a product fails to meet the performance requirements during verification testing, it can be disqualified from the Energy Star® program. The EPA has clear procedures for handling such disqualifications to maintain the integrity of the label.
To browse products that have earned the Energy Star® label, visit https://www.energystar.gov.



Whether you’re upgrading your refrigerator, replacing light bulbs, or purchasing new electronics, the blue Energy Star® label is your assurance that the product has passed all energy e ciency tests. It’s easy to spot and can be found on products ranging from small and major appliances to electronics.
Many large appliances, such as washing machines and clothes dryers, include a yellow Energy Guide label that provides estimated energy use. Comparing these labels can help you determine how much you’ll save with an Energy Star® model compared to a standard model.

While Energy Star® products can cost a little more upfront, their energy savings over time will often cover the di erence. They help reduce your household energy consumption, which could translate to lower utility bills.
As a member of an electric cooperative, choosing energy e cient products benefits not only you but also our entire community. When co-op members use less energy, it lowers overall electricity demand, helping to stabilize rates and reduce costs for everyone.
As you shop for appliances, electronics, or other home equipment this holiday season, look for the Energy Star® label. Whether it’s a new washing machine or energy e cient lighting options, these products are a simple and e ective way to save money and lower energy use.
Jennah Denney writes on consumer and cooperative a airs for the National Rural Electric Cooperative Association.

























From our Co-op family to yours, the Twin County staff would like to wish everyone a very happy holiday season.






































Yazoo Valley Electric's employees have worked through some challenging times recently as crews responded to help with the recovery from two hurricanes in Florida while those remaining picked up the workload at home.
Our employees have enjoyed a great deal of support and kind words along the way, and some of the greatest encouragement has come from children.
Yazoo Valley recently received a handmade card from Mrs. Prescott and Mrs. Duncan’s classes at Wauchula Elementary School along with a photo of them. Wauchula Elementary is served by Peace River Electric Cooperative, which Yazoo Valley assisted with restoration after Hurricane Milton.
While Yazoo Valley had crews working in Florida to restore power, local children contributed artwork at our booth at the Yazoo County Fair. We were impressed with the skills of some of our local young artists.











Yazoo Valley Electric Power Association hosted five talented local juniors for the 2024 Cooperative University.
Makenzie Ray from Yazoo County High School, Caroline Swa ord and Noah Edge from Benton Academy, and Adam Edgar and Anna Grace Davis from Manchester Academy participated in the program where they learned about the history of electric cooperatives and how they continue to serve their communities today. They also learned about the variety of career opportunities in the industry.
Chris Alexander from the Electric Cooperatives of Mississippi gave a presentation on the leadership program and how electric cooperatives consider the program an investment in the future of their communities. Callie Wilson with Cooperative Energy gave a presentation on how electricity is generated and transmitted to electric cooperatives.
Deb McGee and Jeremy Smith from Southwest Electric Cooperative also helped with the interviews and selection process. Ray and Swa ord were selected to represent Yazoo Valley in the Cooperative Youth Leaders program. They will participate in the Cooperative Leaders Workshop in February and a week-long Youth Tour of Washington, D.C. in June.

























Yazoo Valley Electric Power Association recently completed pole top rescue training where employees had to climb a utility pole and safely lower a life-sized dummy. The training, which is conducted annually, is designed to teach employees how to rescue an injured coworker in the event of an accident. Yazoo Valley Safety Coordinator Paul Buxton said it's training that he hopes no one ever needs to use, but it could save someone's life.






Christmas is here and that means precious time spent with family and friends.
There is no greater gift this season than spending time with family.
That’s one of the reasons I love our cover story this month so much.
We spent some time with a special Mississippi family that worked for years on an incredible art project.
Nathan VonMinden, his wife Meleice, and three of their six children made a feature film. The holiday movie, “Steal the Naughty List,” is a stop-motion animation film with a story centered on adventure, personal growth, and the real St. Nicholas.
If you’ve read my columns before, you know I love to watch Hallmark Christmas movies during the holidays.
Now I have a new holiday favorite to add to the list thanks to the VonMindens.
Traditionally, one’s work life and family life are separate. For four years, those lines were blurred as the family struggled and triumphed together during the filmmaking process.
The family admitted it was stressful. But what a journey to undertake.
The final product — available on streaming services including Apple TV/iTunes — is a testament to the family’s hard work, talent, and dedication to a singular goal.
There are lessons in the film and lessons in the story of the VonMindens.
Perseverance, teamwork, and the desire to spread a positive message all come immediately to mind.
So, if you and your family are looking for a funny and heartwarming Christmas adventure film to watch over the holidays, you can’t go wrong with this homegrown future classic.
Today in Mississippi wishes all our members a Merry Christmas and a Happy New Year.

by Michael Callahan
Executive Vice President/CEO Electric Cooperatives of Mississippi





Watching the Mississippi moon rise over a long, tall line of pink Crepe Myrtle trees and white, hibiscus flowers, potted inside an automobile tire.

While a pot of turnip greens comes to a slow boil on an iron stove. I respect Mississippi’s new state flag. Its design expresses what is to be. Full of legacy and diversity. I have been in love with Mississippi since I was a child, digging sweet dirt out of a sandy clay hill to make mud pies. In the evening, between 6 p.m. and 7 p.m., looking out on the green land, and feeling warm breezes blow, it’s spring’s calm before summer’s humidity falls. There is a hummingbird feeding its young. Mississippi calls us home. When hordes of butterflies come in late July to fly over the wildflower field. The wonder takes you back to an antiquity of Indian country. Reminiscence with me, my Mississippi, for you are the wise, your people wiser, and your calm is the glory of God.
by Vendella Brown, a
resident of Olive Branch, and a member of Northcentral Electric.
What’s Mississippi to you? What do you treasure most about life in our state? Send your brief thoughts to Today in Mississippi, news@ecm.coop or mail to P.O. Box 3300, Ridgeland, MS 39158
Submit your beautiful digital photo of life in Mississippi to Today in Mississippi, news@ecm.coop























